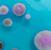

FÖRSTA HJÄLPEN FÖR LUKT
TA 100 % KONTROLL ÖVER DINA

LUKTSANERINGSUPPGIFTER
![]()
TA 100 % KONTROLL ÖVER DINA

LUKTSANERINGSUPPGIFTER
KATALOG 2025
Vaportek luktborttagning med naturens krafter. Komplett produktkatalog och användarhandbok.




SKANDINAVISK/EUROPEISK EXKLUSIV DISTRIBUTÖR FÖR SKADESERVICEBRANSCHEN
FRAMGÅNG I DEN GLOBALA SKADESERVICEBRANSCHEN!
Sedan 1979 har Vaportek varit ledande inom banbrytande produkter för luktsanering baserade på kraften hos naturliga eteriska oljor.









Sedan företagets grundande 1979 har Vaporteks unika teknik och produkter visat sitt värde över hela världen. Idag har produkterna stort erkännande för sin effektivitet och extremt mångsidiga användning för luktsanering inom den globala skadeservicebranschen.
Professionella yrkesverksamma inom skadeserviceindustrin anser idag produkterna som ett oumbärligt verktyg för att bekämpa luktproblem efter brand och vattenskador etc.
Inget annat luktsaneringskoncept är lika mångsidigt och effektivt att använda som Vaportek
AKUTA LUKTPROBLEM, TILL EXEMPEL EFTER EN BRAND, HANDLAR DET OM ATT VARA PROAKTIV, REAGERA SNABBT OCH DÄRIGENOM SKAPA NÖJDA KUNDER.

VAR
PROAKTIV
HJÄLP
DIN KUND OMEDELBART
Vaporteks mångsidiga och effektiva produkter kan omedelbart och utan risk för miljö och människor minska den negativa rök-/sotlukten som härjar en byggnad efter en brand. Vänta inte med att ta bort en akut lukt tills din kund klagar över lukten. Ta initiativ själv, var proaktiv och ta bort eller minska lukten innan kunden kommer till dig – det ger nöjda kunder. Se sidan 19 för detaljerad information om första hjälpen, se även avsnittet Tips & Tricks från sidorna 40-56. Vaportek är inte bara för första hjälpen utan kan naturligtvis användas under hela saneringsprocessen.




VAPORTEK – VETENSKAPLIGT FORMULERAD FÖR ATT NEUTRALISERA LUKT
ETERISKA OLJOR NEUTRALISERAR DÅLIG LUKT OCH BIDRAR SAMTIDIGT
TILL EN LUFTRENANDE OCH ANTISEPTISK EFFEKT
Vaportek-metoden är inte en luktmaskering, men en luktneutralisering baserad på tillämpningen av följande två metoder: "Zwaardemaker Pairs" och "Van der Waals forces".
Se sidorna 16-18.
Vaportek neutraliserar lukt genom kraften i eteriska oljor, men har den positiva bieffekten att många av de använda naturliga oljorna luktar gott. Om det luktar gott – så är det RENT! De flesta försäkringskunder uppskattar en god doft efter en skada.

Luktsinnet är kopplad direkt till det område i hjärnan som kallas det limbiska systemet som styr minne, känslor och instinktivt beteende. Om det luktar rent och gott när du har slutfört ditt skadeservicejobb, uppfattas det av kunden som positivt. Det ger positiv branding för ditt företag och stärker därför din konkurrenskraft. Läs mer på sidan 17.
VAPORTEKS MÅNGSIDIGA
PRODUKTER LÖSER LUKTPROBLEM OCH GER DIG MÅNGA ALTERNATIV
Vaporteks produkter ger dig många möjligheter att vara kreativ när du behöver lösa ett luktproblem. Se hur du utnyttjar produkternas fulla potential i avsnittet Tips & Tricks på sidorna 40-56.
Under de senaste 45 åren har skadeservicebranschen använt de naturliga och kraftfulla ingredienserna i Vaportek-produkter för att skapa doftande och luktfria resultat efter brandskador, vattenskador, liksanering etc. Som en europeisk exklusiv distributör för skadeservicebranschen i över 20 år vet vi på NAC Europe att VAPORTEK GER DITT FÖRETAG NÖJDA KUNDER! Det enda som räknas är nöjda kunder! Använd Vaportek-produkter som ditt mest mångsidiga verktyg för dina olika luktsaneringsuppgifter och upplev att kundnöjdheten ligger i topp varje gång! På de följande sidorna kan du lära dig allt om Vaporteks teknik, produkter och de många alternativ som Vaportek erbjuder.
BASERAD PÅ NATURENS EGNA KRAFTER
Vaportek-tekniken är en unik metod för säker, effektiv och enkel luktborttagning. Metoden har globalt satt en standard för miljö- och användarvänlig luktsanering inom skadeservicebranschen.
En vetenskapligt formulerad och patenterad komposition med mer än 30 olika och 100 % naturliga aromatiska växtextrakt utgör grunden för Vaporteks mångsidiga produktsortiment. Denna komplexa blandning av eteriska oljor kallas Neutrox Gamma och utvecklades i slutet av 70-talet av en ansedd amerikansk läkemedelsproducent för att på ett säkert och effektivt sätt neutralisera dålig lukt inom den amerikanska sjukvården.
Idag används Vaportek med stor framgång i många olika branscher och industrier.
Neutrox Gamma-oljan är hermetiskt förseglad i ett unikt plastmembran. När luft passerar genom membranet, med hjälp av Vaportek-enhetens inbyggda fläkt, diffunderar oljan genom membranet och släpps ut i luften som en torrånga.
Torrångans eteriska oljemolekyler är extremt aktiva och sprids snabbt till hela behandlingsområdet för att effektivt, på molekylär nivå, kapsla in och neutralisera eller luktmodifiera lukter från brand och sotskador, nikotin, urin, mögel, avlopp, avföring, torrstekning/-kokning, svettning, kräkningar, matos, mögel, förruttnelse, husdjur och alla andra lukter av organiskt ursprung.
Torrångan tränger in och behandlar effektivt porösa/halvporösa, släta/hårda ytor och material som trä, betong, tapeter, gips, tegel, textilier, plast mm.
Om du har några frågor om produkterna, priserna eller rabattsystemet är du varmt välkommen att kontakta vårt kontor på info@nac-europe.com eller telefon +45 7442 6292. Vi talar engelska, tyska och skandinaviska.

LUKTSANERINGSKONCEPT
Jesper
Natorp,
managing director
Idag består Vaporteks produktsortiment av flera olika och helt unika produkter, som är baserade på den naturliga, ursprungliga och patenterade Neutrox Gamma-oljeblandningen. Produkterna används med stor framgång i många olika branscher och industrigrenar.

Ozonfri.
Första hjälpen för luktproblem.
Vaportek-metoden är miljö- och användarvänlig.
Använd Vaportek var som helst och när som helst.
Använd Vaportek-produkter före, under och efter ditt skadeservicejobb.
Vaporteks aktiva torrånga behandlar luft, möbler och byggnad samtidigt.
Vaportek - Gör luktneutralisering enkel, snabb och effektiv.





FÖLJANDE SIDOR GER DIG EN KORT ÖVERSIKT ÖVER TEKNIK, ANVÄNDNING OCH PRODUKTER
• Grundades 1979
• Utvecklad för användning i det amerikanska sjukhussystemet
• Familjeägt och -drivet
•
•

Vaportek har sitt
Wisconsin, U.S.A.
MED AKTIV TORRÅNGA
Since 1979

• Eteriska oljor är koncentrerade, aromatiska växtextrakt extraherade från blommor, bark, löv, frukt och rötter med: 1. Pressning 2. Enfleurage dvs. extraktion av eteriska oljor med fetter eller genom 3. Ångdestillation.
• Patenterad blandning av eteriska oljor förseglade i andningsbara membran som frigör unik luktneutraliserande aktiv torrånga.
• Det miljövänliga och användarvänliga alternativet till ozonapparater, termofoggers, ULV-foggers eller miljöskadliga kemikalier.
• Inte bara en "maskering" av lukten, utan en verklig neutralisering enligt Zwaardemaker Pairs-metoden. Holländsk forskare Henrik Zwaardemaker 1857-1930. Se sidan 17.
• Neutrox Gammaolja – Originalet! Unik och komplex blandning av eteriska oljor som kan användas för alla typer av lukt. Vetenskapligt formulerad. Se sidan 36.
• SOS (Smoke Odour Solution) – Unik, komplex och genial blandning av utvalda eteriska oljor. Speciellt formulerad för alla typer av rök- och sotlukt efter trä-, pappers-, syntet- och proteinbränder. Vetenskapligt formulerad. Se sidan 37.
• Lemon och Summer Orange för enkel luktneutralisering och uppfräschning av rum. Fresh & Clean Citrus Concept. Se sidan 38-39.




• Används för att ta bort lukt i händelse av brand-/vattenskador och annan skadesanering, där lukt måste tas bort eller kontrolleras.
• Säker för användning inom sjukvården och privata hem.
• Exempel på användning:
- Matlukt (curry, torrstekning, torrkokning, fisk, etc.)
- Cigarett- och annan tobaksrök.
- Brand- och sotskador.
- Eldningsoljeläckage.
- Lukt av skadedjur.
- Rengöring efter olyckor, dödsfall och kroppsfynd.
- Vattenskador inkl. mögel och avloppsskador.
- Omklädningsrum och utrustning i samband med idrottsanläggningar.
- Restauranger/barer med rök- och/eller matlukt.
- Lukt i bilar/husvagnar/båtar etc.
- Alla industri-/produktionsmiljöer där lukt är ett problem.
- Djurhem och kliniker ... och mycket mer! För bästa resultat är det viktigt att ta bort luktkällan så att luktborttagningen främjas och lukten inte återkommer.




• Optimal prestanda uppnås vid rumstemperaturer mellan 20° - 30°C.
• Låga rumtemperaturer under 10°C kan minska genereringen av aktiv torrånga på patroner och membran.
• Luftcirkulationen hjälper till att sprida torrångan över större områden.
Använd t.ex. en luftfläkt/fläkt för att fördela torrånga från t.ex. Vaporsharken snabbare i det område som ska behandlas.






Perfekt för snabb kontroll av lukt vid större skador, brand i varuhus, fabrikshallar etc.
• Vaporteks unika oljeblandning består av 100 % naturliga eteriska oljor/växtextrakt
• INGET OZON! – INGEN FOGGNING!
• Inget behov av andningsskydd, särskilda tillstånd eller omfattende utbildning.
• Ingen evakuering av boende/skadelidande.
• Ingen fara vid återinflyttning – ingen karantän behövs.
• OBS! Vaporteks produkter kan på grund av innehåll av naturliga ingredienser utlösa allergiska reaktioner hos känsliga personer, förekommer dock sällan. Kontakta NAC Europe om detta kan vara ett problem. Vi har också andra miljövänliga lösningar till luktsanering utan växtextrakt.




AKTIV TORRÅNGA FRÅN VAPORTEK
• Lämnar INGEN klibbig/fet yta när torrånga släpps ut i luften och det behandlade området.
• Tillför INGEN fukt till de behandlade områdena.
• Kräver INGEN evakuering av det behandlade området.
• Kräver INTE frånkoppling av röklarm eller el.
• Kräver INTE andningsskydd.
• Kräver INGEN särskild utbildning eller tillstånd.
• Utgör INTE en antändnings-/explosionsrisk (t.ex. i samband med gasbrännare/rökning).
• Kräver INGET avlägsnande av växter, elektronisk utrustning etc.
• Är säker att använda i bebodda områden.
• Kräver ingen evakuering av invånare/skadelidande.
• Säkert att vistas i behandlade områden under och efter behandlingen.
• Förorsakar inte oxidation eller blekning av material och ytor.
• Skadar inte naturgummi (latex), textilier, läder, lim, PVC eller andra material.
• Kan användas i fuktiga miljöer.
• Bildar inte skadliga biprodukter.
• Snabbare behandling/effekt.
• Restorator och Vaporshark ger dig många års enkel användning med låg strömförbrukning och inget utbyte av UV-lampor.

VAPORTEK = SÄKER
• Behandlar rum upp till 2500 m3 och större, beroende på lukttyp och -intensitet.
• Använd 1-3 membran.
• Membran finns som Neutrox Gamma, SOS (Smoke Odour Solution), Summer Orange och Lemon.
• Membranets livslängd är ca 200-300 timmar.
• Massivt, lätt aluminiumkåpa.
• Mått: 40,5 x 20,5 x 43 cm. Vikt: 5,9 kg.
• 220V – inbyggd 1,5 m3/min. fläkt.
• Populär inom skadeservicebranschen. Snabb första hjälpen för plötsliga luktproblem. Se sidan 19.
Läs mer om Vaporshark på sidorna 20-21 och 54-56.
• Lättanvänd, kompakt elektrisk apparat.
• Behandlar rum upp till 5-600 m3 – beroende på lukttyp och -intensitet.
• Använder utbytbara patroner.
• Patroner finns i Neutrox Gamma, SOS (Smoke Odour Solution), Lemon, Summer Orange och andra doftvarianter.
• Patronens livslängd är ca till 200-300 timmar.
• Den lilla men kraftfulla fläkten fördelar torrånga snabbt och tyst.
• Perfekt för skadesanering, hotellrum, fordon och många andra användningsområden.
• Mått: 16 x 13 x 30 cm. Vikt: 1,7 kg.
Läs mer om Restorator på sidorna 22-23 och 52-53.

LÄS MER OM VAPORSHARK PÅ SIDORNA 20-21
FÖR POPULÄRA APPLIKATIONER
SIDA 54-56


LÄS MER OM RESTORATOR PÅ SIDORNA 22-23
FÖR POPULÄRA APPLIKATIONER
SIDA 52-53







neutrox gamma oil
• Neutrox Gamma Bricks släpper ut en ofarlig torrånga baserad på oljor extraherade från aromatiska växter.
• Torrångan innehåller en komplex sammansättning av över 30 olika, 100 % naturliga växtoljor.
• Torrångan sprider sig snabbt i luften för att omedelbart, på molekylär nivå, inkapsla och neutralisera lukt från rök- och brandskador, vattenskador, avloppsskador, husdjur, skadedjur, torrstekning, torrkokning, kemikaliespill, förruttnelse, mögel, fukt, avloppsvatten, avfall, matos, svett, urin, kräkningar, djur etc.
• Kan med fördel placeras i avfuktnings-, luftrenings- och ventilationsutrustning för att kontrollera lukt i samband med skadesanering.
Läs mer om Neutrox Gamma Bricks på sidorna 26-29 och 40-45.
• Aroma Bricks är identisk i form, struktur och beteende med Neutrox Gamma Bricks, men är baserad på 6 utsökta doftvarianter som alla tillfredsställer luktsinnet. Aroma Bricks avger en väldoft i de behandlade rummen, vilket undertrycker den psykologiska kvarvarande lukten som kan uppstå hos skadelidande efter t.ex. en brand, etc.
• Aroma Bricks gör dina kunder nöjda.
• Kan med fördel placeras i avfuktnings-, luftrenings- och ventilationsutrustning för att kontrollera lukt.
• Aroma Bricks kan också användas i dammsugare, och är också populära i samband med möbelrengöring, använd din fantasi!
• Aroma Bricks finns i dofterna: Lemon, Summer Orange, Ocean, Berry, Linen och Cool Green.
Läs mer om Aroma Bricks på sidorna 26-29 och 40-45.
LÄS MER OM NEUTROX GAMMA BRICKS OCH AROMA BRICKS PÅ SIDORNA 26-29
FÖR POPULÄRA APPLIKATIONER
SIDA 40-45

BRICKS FINNS NU OCKSÅ MED


BESTSELLER SKADESERVICE











• Speciellt utvecklad för luktsanering vid rengöring av ytor efter brandskador etc. Tillsätts i tvätt-/sköljvattnet.
• För användning på golv, väggar och andra ytor. Vaporteks populära ECOZ-koncentrat är vattenblandbara mikroemulsioner av eteriska oljor. Det är vetenskapligt bevisat att naturliga eteriska oljor har förmågan att neutralisera lukt. Vaporteks ECOZ-produkter är en av få produkter på marknaden som innehåller och består av äkta eteriska oljor.
• Biologiskt nedbrytbart, giftfri, ej frätande, lämnar inga rester och feta ytor.
• Finns i dofterna: Classic Neutral, SOS, Lemon, Summer Orange och Linen. ECOZ luktar bara bäst.
LÄS MER OM ECOZ PÅ SIDORNA 30-31
FÖR POPULÄRA APPLIKATIONER

SIDA 46-49

BIO-C (BIOLOGISK NEDBRYTNING OCH LUKTSANERING)
• Bioenzymatiskt, vattenblandbart koncentrat för luktneutralisering och sönderdelning av organiskt material.
• Specialprodukt från VAPORTEK bestående av en komplex blandning av över 30 olika eteriska oljor (100 % naturliga växtextrakt) och en suspension av mikroorganismer och enzymer.
• BIO-C främjar och påskyndar den naturliga organiska nedbrytningsprocessen genom att använda en kraftfull blandning av speciella bakteriekulturer samt en stabiliserad komposition av lipas-, cellulas-, proteas- och amylasenzymer.
• Tar bort och bryter ner lukt från avföring, förruttnelse, urin, rök, fettavskiljare, kräkningar, fukt, mögel, svett, djur, hushållsavfall och alla andra lukter av biologiskt/ organiskt ursprung.

BESTSELLER SKADESERVICE



LÄS MER OM BIO-C PÅ SIDORNA 32-33
FÖR POPULÄRA APPLIKATIONER
SIDA 50-51
BIO-C TAR BORT BIOLOGISK/ ORGANISK LUKT






• Innehåller ett membran – tillräckligt för att behandla rum upp till 700 m3 och flera tusen m3 när det placeras i ventilationskanaler.
• Kan användas framför en luftfläkt eller placeras i ventilationssystem, avfuktningssystem etc.
• Finns som Neutrox Gamma, SOS, Lemon eller Summer Orange.
• Vridbar aluminiumskiva i ändarna möjliggör reglering av torrångans intensitet. Stäng med aluminiumskivan för att spara för senare användning. Kan levereras med stativ.
• Livslängden är ca 250-300 timmar.
• Mått: 14,6 x 9,5 cm diameter. Vikt: mindre än 500 g.
Läs mer om HDS-patronen på sidorna 34-35
• Nature Fresh är ett passivt torrångsystem i två storlekar.
• Inte elektrisk, bara vrid på den justerbara toppen eller bottnen för att kontrollera luftgenomströmningen.
• Perfekt för områden som kräver kontinuerlig luktkontroll/deodorisering eftersom källan till dålig lukt är ihållande.
• För bebodda områden och applikationer inom vårdsektorn, sjukhussystemet, industrin, djursjukhus, gym, etc.
• Skadeservice – kan placeras i avfuktningssystem i samband med uttorkning av byggnader etc.
• Levereras med Neutrox Gamma-pappersmembran, men Neutrox Gamma- och Aroma Bricks kan också användas.
Artikelnummer
56-1302 Liten version
56-1303 Stor version
- EFFEKTIV LÄS MER OM HDS PATRONEN PÅ SIDORNA 34-35

FÖR POPULÄRA APPLIKATIONER
SIDA 34-35


KONTAKTA OSS FÖR MER INFORMATION OM NATURE FRESH

Kedja med 2 clips för att hänga Neutrox Gamma Bricks, SOS Bricks, Aroma Bricks eller EZ-Disk.


Artikelnummer 56-1345 Alligator Clip (Simple Clip System)
med kardborreband. EZ-Twist släpper ut torrånga utan att använda batterier. Deodoriseringen justeras genom att vrida locket på EZ-Twist.
EZ-Twist använder EZ-Disk (se sidan 15). Unik torrånga – inga aerosoler eller gelé.
TIPP!
Kan också användas med Neutrox Gamma Bricks och Aroma Bricks. Bricks halveras i tjocklek med en hobbykniv och de två halvorna placeras på vardera sidan av mittstiftet. Se bild.
Artikelnummer 56-1999 EZ-Twist Levereras i påsar med 12 st.

KONTAKTA OSS FÖR MER INFORMATION OM OLIKA LUFTFLÄKTAR
FÖR POPULÄRA APPLIKATIONER
SIDA 40-45

KONTAKTA OSS FÖR MER INFORMATION OM EZ-TWIST






EZ-Disk, specialpappersfiberskiva (cellulosa) mättad med naturliga aromatiska oljor.
Används i EZ-Twist och Vaportronic.
Neutrox Gamma Bricks och Aroma Bricks kan också användas i Vaportronic. Se bild till höger.
Artikelnummer 56-1227 Vaportronic aromdispenser
Finns i dofterna:
56-1323 Neutral/Neutrox Gamma-olja (påse med 12 st.)
56-1939 Ocean (påse med 12 st.)
56-1955 Summer Orange (påse med 12 st.)
56-1322 Lemon (påse med 12 st.)
56-1321 Potpourri (påse med 12 st.)
56-1339 Berry-Bär (påse med 12 st.)
56-1338 Orchard-Fruktträdgård (påse med 12 st.)
56-1913 Cool Green (påse med 12 st.)
Vi rekommenderar Aroma Bricks i Vaportronic pga. prisbesparingar jämfört med EZ-Disk.
• Lättanvänd, kompakt elektrisk apparat.
• Justerbar effekt.
• Avsedd för permanent installation mot beständiga/ permanenta luktproblem.
• Behandlar rum på upp till 600 m3 – beroende på lukttyp och -intensitet.
• Använder utbytbara Optimum 4000 patroner: Finns i Neutrox Gamma, SOS (Smoke Odour Solution), Lemon, Summer Orange och andra doftvarianter.
• Patronens livslängd är ca 3-5 månader.
• Praktiskt taget tyst drift.
• Stabil konstruktion med vinylpläterat stålhus med plastlock i båda ändar.
• Mått: 13 x 13 x 30 cm. Vikt: ca 2 kg.
• För omklädningsrum, hotell/receptioner, sjukhus, sjukhus/vårdhem, djursjukhus, kennlar, fängelser, kontorsmiljöer, gym och mer.
- EFFEKTIV

KONTAKTA OSS FÖR MER INFORMATION OM EZ-DISK OCH VAPORTRONIC




MER OM OPTIMUM 4000 PÅ SIDORNA 24-25



SAMTIDIGT MED EN RENANDE OCH ANTISEPTISK EFFEKT
VAN DER WAALS FORCES:
Detta hänvisar till den interaktiva energin som äger rum mellan ämnen av extremt liten storlek. Det är krafter som kollision, avstötning och attraktion som styr beteendet hos icke-laddade partiklar som finns i gasform. Detta förklarar kopplingsprocessen mellan eteriska oljor och de luktande ämnena när de är i ångtillstånd.
ZWAARDEMAKER PAIRS:

OLJEMOLEKYL
(t.ex. enbärsolja)
LUKTMOLEKYL
(t.ex. smörsyra/buturic acid)
Zwaardemaker Pairs är baserad på en vetenskaplig upptäckt, vilket innebär att blandning eller kombination av luktämnen inte ger någon lukt. Denna "luktparring" har visat sig vara möjlig med ett begränsat urval av eteriska oljor och illaluktande ämnen. Denna interaktion mellan luktande ämnen är ett fenomen som upptäcktes i slutet av 1800-talet av den flamländska forskaren Hendrik Zwaardemaker
STÄRK DITT
FÖRETAGS IMAGE GENOM ATT LÄGGA TILL ETT DISKRET
OCH POSITIVT DOFT-AVTRYCK I DITT SKADESERVICEJOBB SOM KUNDEN KOMMER IHÅG DIG FÖR!
Det har vetenskapligt bevisats att vi människor till stor del styrs känslomässigt av vårt luktsinne. Näst efter synen är luktsinnet det som har störst inflytande på människor.
Tänk dig att du genom doft kan göra lite extra för din kund och de kommer ihåg dig för det.




Det har vetenskapligt bevisats att vi människor till stor del styrs känslomässigt av vår luktsans. Enligt synen är luktsinnet det av alla våra sinnen som har störst inflytande på människor.
MÄNNISKOR LOCKAS AV GOD LUKT/DOFT!
Vaporteks specialoljor och vätskor är baserade på 100 % naturliga och mycket effektiva doftande eteriska oljor, som nu i 45 år över hela världen har skapat övertygande resultat inom luktbehandling i den profesionella skadeservicebranschen.
Det är vetenskapligt bevisat att endast naturliga eteriska oljor har förmågan att neutralisera lukt. Vaporteks teknik är inte en maskering av den dåliga lukten, men fungerar enligt en vetenskapligt beprövad metod som kallas "Zwaardemaker Smell System" eller "Zwaardemaker Pairs".
Vaporteks teknik bygger på studier och forskning av: Hendrik Zwaardemaker
Född den 10 maj 1857, Haarlem Död 19 september 1930, Utrecht Nationalitet holländska Vetenskaplig karriär Fields Physiology
Institutioner University of Utrecht Största vetenskapliga arbetet "Physiologie of Olfaction" publicerat i 1895

INGEN MASKERING, MEN EN NEUTRALISERING AV LUKT
Ett viktigt bidrag från Zwaardemakers studier är begreppet luktkonjugat. Zwaardemaker upptäckte att vissa lukter kunde undvika att uppfattas av luktsinne om de blandades med olika eteriska oljor. Denna kombination av eteriska oljor och lukt kallas "Zwaardemaker Pairs" (or Z-pairs).
DÅLIG LUKT VANLIGA LUKTKÄLLOR Z-PAIR ETERISKA OLJOR AKTIV BESTÅNDSDEL
Smörsyra Kräkningar, förruttnelse, härskna mejeriprodukter ENBÄRSOLJA
Klor VANILJ VANILJ
Ammoniak Urin ROSOLJA IONONE
Tobak Cigarettrök VINTERGRÖNEOLJA METYLSALICYLAT
Mysk BITTERMANDELOLJA BENSALDEHYD
Gummi CEDEROLJA
Skatol Avföring, Stenkolstjära CEDEROLJA
Mercaptan Naturgas EUKALYPTUSOLJA EUCALYPTOL
Vaporteks produkter neutraliserar lukt genom kraften i de fina eteriska oljorna som fungerar enligt Zwaardemaker Pairs-metoden. Men sedan 1895, när Hendrik Zwaardemaker presenterade sina första studier har mycket hänt. Man kan antagligen tillskriva grundaren av Vaportek Mr. Jack Bryson en stor del av äran för att vara en av de människor som har lyckats se potentialen hos eteriska oljor och utnyttjat potentialen hos dessa oljor till fullo och på grundval av detta skapat ett företag med produkter som har vunnit stor respekt över hela världen inom skadeservicebranschen och många andra områden. Under de senaste 45 åren har skadeservicebranschen använt de naturliga ingredienserna i Vaportek-produkter för att skapa doftande och luktfria utrymmen efter brandskador, avloppsskador, likskador etc.
Rum/anläggningar som har behandlats med Vaportek luktbehandlingsprodukter kommer inte att maskeras med en öronbedövande doft – utan kommer att framstå som fräscha och doftande – något som det mänskliga luktsinnet uppfattar som mycket positiv. Därför upplever de allra flesta Vaportek-kunder våra dofter som mycket positiva. Det väcker glädje hos den skadade att återvända till sitt nysanerade hus som är luktfritt men där skadelidande också känner en ny touch av t.ex. doftande citrusdoft... DET ÄR VAPORTEK!
Många försäkringskunder som har haft brandskador eller liknande där skadeståndsföretaget har använt Vaportekprodukter för luktsanering, kontaktar oss för att få möjlighet att köpa och använda Vaportek-produkter i sitt dagliga liv för att behandla lukt från husdjur, cigarettlukt, matos eller vad som för närvarande är relevant för dem.
I andra situationer kan det vara önskvärt att skapa helt luktfria utrymmen – NAC Europe kan också hantera detta. Vi har ett helt program med andra högteknologiska produkter som fungerar genom oxidation. Dessa kan användas separat eller i kombination med Vaportek. Det här är vad vi kallar det bästa av två världar. Dessa koncept presenteras i NACs nya "Odour Management Concept". Se sidan 59 för mer information.

Folk frågar ofta om Vaporteks teknik maskerar eller verkligen tar bort dålig lukt. Svaret är: Vaportek eliminerar organiska lukter.
LUKTMASKERING KONTRA LUKTNEUTRALISERING
Att maskera är att öka den totala luktintensiteten för att eftertryckligt "täcka över" en befintlig dålig lukt. Det innebär att du introducerar en ny lukt som luktar starkare än den problematiska lukten du vill ta bort. Detta resulterar i ett ytterligare bombardemang av upplevda lukter som inte gör något för att ta bort källan till den ursprungliga dåliga lukten.
Att neutralisera är att ta bort eller orsaka illaluktande molekyler som inte uppfattas på molekylär nivå genom att direkt motverka åtgärder med en ytterligare substans eller blandning, i detta fall Vaporteks unika blandningar av rena eteriska oljor. De illaluktande molekylerna ändras sedan genom en kemisk interaktion som kallas luktparning eller inkapsling (se även Zwaardemaker-par sidorna 16-17) till en ny molekylär form, som antingen inte längre luktar eller inte är tillräckligt flyktig för att uppfattas. På detta sätt reduceras den illaluktande molekylen i den grad att den försvinner därför att den har brutits ned till oigenkännlighet.
När Vaporteks eteriska oljeblandningar släpps ut i luften som en torrånga, reagerar de direkt med illaluktande molekyler i luften. Denna molekylära, kemiska interaktion möjliggör för Vaporteks produkter att effektivt neutralisera dofter av organiskt ursprung.
VARFÖR ETERISKA OLJOR?
Anledningen till att Vaportek tillför en extra doft (som felaktigt tillskrivs maskeringsegenskaper) beror på Vaporteks komplexa formel som består av rena eteriska oljor och den exakta komplexiteten hos oljeformeln, som går ett steg längre och effektivt tar bort källan till de illaluktande molekylerna genom kapsling och luktparning (Zwaardemaker Pairs). Även om det finns ett stort antal eteriska oljor kan inte alla neutralisera organiska lukter som rök, urin, förruttnelse eller mögel etc.
Vaportek har noggrant formulerat den rätta blandningen av oljor som behövs för effektiv och permanent luktborttagning. Därför är Vaporteks teknik så unik. Våra blandningar av eteriska oljor gör det möjligt att neutralisera ett stort antal luktframkallande ämnen som aldehyd, amin, diamin, sulfid, lakton, karboxylsyra, ester, karbylaminer, keton, skatol, mekaptan och andra karboner.
Det är tack vare Vaporteks eteriska oljeblandningar som Vaportek kan vara stolta över att erbjuda sina kunder en grön lösning på deras luktproblem, istället för att tvingas använda hårda kemikalier och ozonproducerande maskiner. Många befintliga lösningar

för luktborttagning utsätter både boende/skadelidande och yrkesverksamma som använder utrustningen för skadliga ämnen som kan leda till andningssjukdomar och lungskador. Ozonmaskiner etc. kan dessutom orsaka skador på vår naturliga miljö. Vaporteks teknik är CFC-fri, giftfri och VOC-kompatibel.
VARFÖR TORRÅNGA?
Vaportek skiljer sig dessutom från konkurrenterna med sin leverans-/diffusionsteknik inom torrånga, som tillför noll fukt till behandlingsområdet och som annars inte känns i det behandlade rummet, förutom den diskreta doften av eteriska oljor. Vaporteks torrångteknik producerar inte skadliga ozon- eller hydroxylradikaler och innebär inte användning av kall- och termofogger. Vaporteks torrånga har hög rörlighet i luften och kan tränga säkert igenom porösa material som gipsskivor, trä, mattor, cement, tegel, isolering och andra ytor på ett sätt som konkurrenternas produkter inte kan.
LITA PÅ VAPORTEK
Vaportek är företaget bakom den banbrytande torrångtekniken som bygger på de unika eteriska oljorna. Vaportek ligger många år före kopieringsprodukterna från företag som fortfarande kämpar för att uppnå den perfekta balansen som Vaportek hittade och gjorde perfekt 1979. Lita på Vaportek och företagets ursprungliga oljeblandningar för effektiv och permanent luktborttagning.
TA BORT DOFTER AV ORGANISKT URSPRUNG
Här är några exempel på dofter av organiskt ursprung som Vaportek-produkter är kända för att effektivt kunna neutralisera: rök, nikotin, urin, svett, kräkningar, matos, matlukt, mögel, fukt, sot/röklukt efter brand, förruttnelse och många fler.




DET FINNS MÅNGA GODA SKÄL ATT ANVÄNDA VAPORTEKS PRODUKTER – HÄR ÄR ETT AV DEM!
VID AKUTA LUKTPROBLEM HANDLAR DET OM ATT VARA PROAKTIV, REAGERA SNABBT OCH DÄRIGENOM SKAPA NÖJDA KUNDER.
Förutom det faktum att Vaporteks unika teknik och produkter under de senaste 45 åren har bevisat sitt värde och effektivitet i den globala skadeservicebranschen, och idag är populära produkter för fullständig och permanent deodorisering under hela saneringsprocessen, sticker Vaportek-produkterna särskilt ut genom sin mångsidighet och extremt snabba effekt, särskilt vid plötsliga luktproblem.

Här ger Vaportek-produkter mycket snabbt och effektivt första hjälpen mot lukt, vilket innebär att troliga klagomål och olägenheter om t.ex. rök- och sotlukt efter brand i privata hem, lägenhetskomplex, företag, trapphus, köpcentra, produktionslokaler etc. kan helt förhindras om en eller flera av de populära och snabbverkande Vaportek-produkterna som t.ex. en VaporShark, en Restorator eller de populära Neutrox Gamma Bricks, SOS Bricks eller Aroma Bricks.

Resultat = Nöjda kunder som känner att du löser ett luktproblem för dem här och nu. Dina proaktiva och snabba insatser kommer de att komma ihåg. Det stärker ditt företags image!
Se hur du utför första hjälpen med Vaportek-produkter under avsnittet Tips & Tricks på sidorna 40-56.
Rekommenderad behandling av plötslig eller ihållande lukt i samband med skador. Extremt säker och effektiv behandling.
• Inget ozon
• Populärt bland rengörings- och skadesaneringsföretag över hela världen
• Omedelbara resultat utan skadliga hälsoeffekter
• Snabb luktborttagning främjar kundnöjdheten
• Luktborttagning är permanent för svåra lukter
• Rekommenderas av försäkringsbranschen
SOS- (Smoke Odour Solution) eller Neutrox Gamma-olja kan användas för att behandla alla typer av röklukt efter syntetiska bränder, trä- och papperseldar, proteinbränder etc.
Installera utrustningen i början av saneringsarbetet för att omedelbart minska lukten för sanerare och boende.
Säker för användning i bebodda områden under sanering. Förenklar och påskyndar rengöringen.

Lukt efter översvämningar och fuktskador avlägsnas effektivt under behandlingen – perfekt för användning under torkningsprocessen. Använd till exempel Neutrox Gamma Bricks i avfuktare.
Även djurlukt kan avhjälpas med korrekt behandling. Perfekt
även för att ta bort liklukt och liknande.
KRAFTFULL, EFFEKTIV OCH MÅNGSIDIG LUKTBEHANDLINGSAPPARAT SOM PRODUCERAR VAPORTEKS UNIKA AKTIVA TORRÅNGA – DET MILJÖVÄNLIGA ALTERNATIVET TILL OZONBEHANDLING
PRODUKTINFORMATION
Helt unik och extremt effektiv anordning för permanent avlägsnande av dålig lukt. Lämnar de behandlade rummen med en ren, fräsch och naturlig lukt. Ett utmärkt och miljövänligt alternativ till ozonbehandling.
VaporShark är en enkel bärbar elektrisk apparat som använder en ofarlig teknik som snabbt, effektivt och permanent tar bort dålig lukt och förnyar luften inomhus. VaporShark använder Vaporteks patenterade membransystem, som innehåller en komplex blandning av över 30 olika och 100 % naturliga eteriska oljor, dvs. pressade och på annat sätt utvunna extrakt från växtriket, såsom eukalyptus, ceder, pepparmynta, kamfer, tall, lavendel, citrusfrukter etc.
När luft passerar över membranet, med hjälp av VaporSharks inbyggda fläkt, diffunderar oljan genom membranet och släpps ut i luften som en torrånga. Torrångans vegetabiliska oljemolekyler är extremt aktiva. De sprider sig snabbt till hela behandlingsområdet och tränger effektivt in i porösa ytor såsom trä, betong, tapeter, gips, tegel, isoleringsmaterial, textilier etc. och sätter sig på icke-porösa ytor för att snabbt och effektivt på molekylär nivå inkapsla och neutralisera eller luktmodifiera luktproblem från brandoch sotskador, nikotin, urin, mögel, avlopp, avföring, torrstekning/torrkokning, svett, kräkningar, matos, förruttnelse, husdjur och alla andra lukter av organiskt ursprung.


Luftintag
Justerbart spjäll
Strömbrytare
Luftutlopp
1,8 m kabel (jord)
Energiförbrukning: 36 watt

FÖR POPULÄRA APPLIKATIONER
SIDAN 54-56
ANVÄNDNINGSOMRÅDEN

Används av skadeföretag över hela världen för att ta bort lukt efter brandskador (protein, trä/ papper eller syntetiska bränder), vattenskador, avloppsskador, torrstekning/torrkokning, kemiskt spill, liksanering, förruttnelse etc.
Handtag för enkel transport
50/60 Hertz 230 V 90 m3/t Fläkt
Solitt aluminiumskåp Luftutlopp
Membranstativ med membran
Låshasp med lås

Luftintag




KRAFTFULL, EFFEKTIV OCH MÅNGSIDIG LUKTBEHANDLINGSAPPARAT
SOM PRODUCERAR VAPORTEKS UNIKA AKTIVA TORRÅNGA





MILJÖVÄNLIG TEKNIK
Vaportek-tekniken är baserad på naturliga växtextrakt och är inte skadlig för människor, och är därför ett bättre val än användning av ozonanordningar samt applicering av kemisk rök/dimma med termofogger och ULV-kallfogger. Till skillnad från ozonbehandling skadar VaporSharken inte textilier, gummi, lim etc. Fukt släpps inte ut i de behandlade rummen och därför elimineras risken för skador. Eftersom metoden är ofarlig för människor är det inte nödvändigt att evakuera rum som behandlas med VaporSharken eller evakuera de boende. Du kan bo i de behandlade rummen medan VaporSharken arbetar.
Denna mycket mångsidiga luktbehandlingsapparat är avsedd för större uppgifter där snabba och effektiva resultat önskas. Avsedd för rum i storlekar upp till 2500 m3 och mer beroende på lukttyp och -intensitet.
VAPORSHARK art.nr. 56-1229 MEMBRAN FINNS I FÖLJANDE AROMER
56-1352 Membran - Neutrox Gamma
56-1766 Membran - SOS
56-1758 Membran - Lemon
56-1757 Membran - Summer Orange
VAPORSHARK BEHANDLAR LUFT, MÖBLER OCH BYGGNAD SAMTIDIGT
VAPORSHARKENS ENKLA OCH ROBUSTA DESIGN GER DIG MÅNGA ÅRS ENKEL DRIFT UTAN UNDERHÅLLSKOSTNADER OCH MED MINIMAL STRÖMFÖRBRUKNING – ”JUST PLUG AND PLAY”
NOTERA!
• Detta system är ett säkert och effektivt alternativ till ozon, ULV-fogging (kall och termisk).
• Inga hälsorisker.
• Användning av personlig skyddsutrustning, t.ex. mask, är inte nödvändigt.
UTVALDA SPECIFIKATIONER
• Bearbetar ytor upp till 2500 m³ och mer.
• Stabil lättviktskonstruktion i aluminium.
• Mått: 40,5 x 20,5 x 43 cm.
• Vikt: 5 kg.
• Membran som sätts in i VaporShark och avger aktiv luktneutraliserande torrånga.
• Strömförbrukning: 36 watt.
• Membranets livslängd ca 200-300 timmar.
ANVÄNDNING AV VAPORSHARK
• Skadeservice
• Livsmedelproduktion
• Slakterier
• Organisk avfallshantering
• Djurinternat
• Stora växthus
• Avloppssystem och installationer
• Extraktorer/kåpor i livsmedelsproduktion/ restauranger etc.
• Stora hallar och mötesrum, hotell/ utställningscenter etc.
• Städföretag och många andra.






Tips: Använd ECOZ våtluktsanering i tvätt-/ sköljvattnet när du rengör brandskador.
OZON- OCH AEROSOLFRI METOD = MAXIMAL SÄKERHET FÖR ANVÄNDARNA
VAPORSHARK APPARATET BEHANDLER LUFTEN, LØSØRE/INDBO OG BYGNINGER SAMTIDIG.
KOMPAKT, EFFEKTIV OCH MÅNGSIDIG LUKTBEHANDLINGSAPPARAT SOM PRODUCERAR VAPORTEKS
UNIKA AKTIVA TORRÅNGA – DET MILJÖVÄNLIGA ALTERNATIVET TILL OZONBEHANDLING
Bruksanvisning på sidan
Extra kraftigt utformat handtag
Strömbrytare
Produktion av aktiv luktneutraliserande torrånga
Galvaniserat stålnät
Öppning för insättning av patroner med aktiv olja

Intern 220 volt fläkt.

Kapacitet upp till 1,4 m³ per. minut.
FÖR POPULÄRA APPLIKATIONER
SIDAN 52-53
Energiförbrukning: 11 watt


Plastsladdar med lock
Luftintag

180 cm nätsladd till 220 volt AC
Slitstarkt vinylklätt 2,2 mm stålhus
Patron med aktiv olja för luktbehandling (säljs separat)


RESTORATOR BEHANDLAR LUFT, MÖBLER OCH BYGGNAD SAMTIDIGT
OBSERVERA!
• Detta system är ett säkert och effektivt alternativ till ozon, ULV-foggning (kall och termisk).
• Inga hälsorisker.
• Användning av personlig skyddsutrustning är inte nödvändigt.
RESTORATOR art.nr. 56-1226
PATRONER FINNS I FÖLJANDE AROMER:
56-1387 Standardpatron för Restorator/Optimum 4000 - Neutrox Gamma
56-1769 Standardpatron för Restorator/Optimum 4000 - SOS
56-1759 Standardpatron för Restorator/Optimum 4000 - Lemon
56-1756 Standardpatron för Restorator/Optimum 4000 - Summer Orange
56-1765 Patron för Restorator/Optimum 4000 - Neutral m. 10 % lemon
56-1369 Patron för Restorator/Optimum 4000 - Berry-Bär
56-1370 Patron för Restorator/Optimum 4000 - Orchard-Fruktträdgård
56-1776 Patron för Restorator/Optimum 4000 - Ocean




KOMPAKT, EFFEKTIV OCH MÅNGSIDIG LUKTBEHANDLINGSAPPARAT SOM PRODUCERAR VAPORTEKS
UNIKA AKTIVA TORRÅNGA – DET MILJÖVÄNLIGA ALTERNATIVET TILL OZONBEHANDLING
Restoratoren är en enkel bärbar elektrisk apparat som använder en ofarlig teknik som snabbt, effektivt och permanent tar bort dålig lukt och förnyar luften i inomhusutrymmen. Restorator använder Vaporteks patenterade membransystem, som innehåller en komplex blandning av över 30 olika, 100 % naturliga, eteriska oljor, dvs pressade och på annat sätt utvunna extrakt från växtriket, såsom eukalyptus, ceder, pepparmynta, kamfer, tall, lavendel, citrusfrukter etc.
När luft passerar genom membranet med hjälp av Restoratorens inbyggda fläkt diffunderar oljan genom membranet och släpps ut i luften som en torrånga. Torrångans vegetabiliska oljemolekyler är extremt aktiva och sprids snabbt till hela behandlingsområdet och tränger effektivt in i porösa ytor såsom trä, betong, tapeter, gips, tegel, textilier etc. och sätter sig på icke-porösa ytor för att snabbt och effektivt inkapsla och neutralisera eller luktmodifiera luktproblem från brand och sotskador, nikotin, urin, mögel, avlopp, avföring, torrstekning/torrkokning, svett, kräkningar, matos, mögel, förruttnelse, husdjur och alla andra lukter av organiskt ursprung.
MILJÖVÄNLIG TEKNIK
Tekniken är baserad på naturliga växtextrakt och är inte skadlig för människor och är därför ett bättre val än användning av ozonanordningar, kemisk foggning och sprayning av aerosoler, och till skillnad från ozonbehandling skadar Restoratoren inte textilier, gummi eller lim. Fukt släpps inte ut i de behandlade rummen och risken för skador elimineras därför. Eftersom metoden är ofarlig för människor är det inte nödvändigt att evakuera rum som behandlas med Restoratoren. Man kan uppehålla sig i de behandlade rummen medan Restoratoren arbetar.
Denna mycket mångsidiga luktborttagningsanordning är avsedd för områden där snabba resultat önskas, från små rum som bilens förarhytt, hotellrum, till något större rum och upp till rum på 600 m3 eller ca 250 m2
RESTORATOR BEHANDLAR LUFT, MÖBLER OCH BYGGNAD SAMTIDIGT
RESTORATORENS ENKLA OCH ROBUSTA DESIGN GER DIG MÅNGA ÅRS ENKEL DRIFT UTAN UNDERHÅLLSKOSTNADER OCH MED MINIMAL STRÖMFÖRBRUKNING – "JUST PLUG AND PLAY"
UTVALDA SPECIFIKATIONER
• Behandlar områden upp till 566 m³ eller mer beroende på luktintensitet och lukttyp.
• Hållbar konstruktion med 2,2 mm vinyl beklädnad av stålhölje och ABS-ändlock.
• Mått: 16 cm x 13 cm x 30 cm.
• Vikt: 1,7 kg.
• Patroner sätts in i Restoratoren och avger aktiv luktneutraliserande torrånga.
• Strömförbrukning: 11 watt.
• Membranliv: ca 200-300 timmar. OZON- OCH AEROSOLFRI METOD = MAXIMAL SÄKERHET FÖR ANVÄNDARNA
ANVÄNDNING AV RESTORATOR
• Luktsanering efter brand och vattenskador etc.
• Luktbehandling av hotellrum och liknande
• Biluthyrningsföretag (röklukt etc. i bilar)
• Bilhandlare/campinghandlare
• Sjukhus och vårdhem (sjukvård i allmänhet)
• Städföretag
• Idrottshallar
• Fastighetsmäklare/fastighetstjänster
• Industri i allmänhet
… och många fler.

Tips: Använd ECOZ våtluktsanering i tvätt-/ sköljvattnet när du rengör brandskador.





EFFEKTIV LUKT-/LUFTBEHANDLING – DET MILJÖVÄNLIGA ALTERNATIVET TILL OZON OCH AEROSOLER ETC.
Optimum 4000 för permanent installation mot ihållande lukt-/luftproblem.
Åtkomst till patron
Produktion av aktiv luktneutraliserande torrånga
Justering av doft-/ torrångeintensitet Strömbrytare
Neongrön indikatorlampa
Bruksanvisning på undersidan


Art.nr.

OBSERVERA!
• Detta system är ett säkert och effektivt alternativ till ozon, ULV-foggning (kall och termisk).
• Inga hälsorisker.
Väggfäste med lås för permanent installation kan köpas

Vinylklätt stålhus

Optimum 4000 patron
Engångspatron finns i flera doftvarianter. Patronerna varar ca 3-5 månader.
OPTIMUM 4000 art.nr. 56-1216
PATRONER FINNS I FÖLJANDE AROMER:


56-1387 Standardpatron för Restorator/Optimum 4000 - Neutrox Gamma
56-1769 Standardpatron för Restorator/Optimum 4000 - SOS
56-1759 Standardpatron til Restorator/Optimum 4000 - Lemon
56-1756 Standardpatron för Restorator/Optimum 4000 - Summer Orange
56-1765 Patron för Restorator/Optimum 4000 - Neutral m. 10 % lemon
56-1369 Patron för Restorator/Optimum 4000 - Berry-Bär
56-1370 Patron för Restorator/Optimum 4000 - Orchard-Fruktträdgård
56-1776 Patron för Restorator/Optimum 4000 - Ocean




EFFEKTIV LUKT-/LUFTBEHANDLING
Optimum 4000 för permanent installation mot ihållande lukt-/luftproblem.
FUNKTIONER OCH FÖRDELAR
Optimum 4000 är Vaporteks ursprungliga torrångsystem, som först användes på canceravdelningar och andra medicinska anläggningar 1979. Optimum 4000 är främst avsedd för platser med förnybar el. permanenta luktproblem. Optimum 4000 avger en ofarlig torrånga när den luktneutraliserande växtoljan som är förseglad i det inre membranet i patronen diffunderar ut genom membranytan när luften passerar. Ta bara bort locket från patronen och sätt in den från baksidan av apparaten och ställ in önskad torrångstyrka. Den torrånga som släpps ut från Optimum 4000 transporteras av luftströmmar snabbt i hela området som ska behandlas och kommer snabbt att kontrollera och eliminera lukt orsakad av nikotin, fukt/mögel, mat, biologisk lukt, svett, avföring, kräkningar, matos, förruttnelse, husdjur och alla andra lukter av organiskt ursprung. Den aktiva torrångan behandlar luft, lösöre och byggnad samtidigt.
PLACERING
Eftersom torrånga är tyngre än luft rekommenderas att du placerar Optimum 4000 så högt som möjligt. Enheten placeras på en hård yta och ska endast placeras på en plats där den är synlig under normal användning. Fram- och baksidan av Optimum 4000 får inte täckas. När den används i områden där säkerhet är en prioritet kan Optimum 4000 monteras i ett väggfäste med ett lås för att undvika obehörig åtkomst till kontrollknappen och stöld av enheten.
- Bättre än ULV-fogger – lämnar ingen fukt, praktiskt taget tyst och behandlar större områden.
- Bättre än aerosoler – säker formulering och mer miljövänliga aktiva ingredienser.
- Bättre än ozonanordningar – använder ofarliga eteriska oljor, oxiderar inte material och kräver ingen evakuering av behandlingsområden.
Styrkekontrollen säkerställer fullständig kontroll i samband med eventuella luktproblem. En termiskt skyddad inbyggd fläkt fungerar tyst och använder endast 16 W effekt. Patronerna varar ca 3-5 månader.
SPECIFIKATIONER
• Behandlar rum upp till 500-600 m³ eller mer.
• Tyst drift.
• Stabil konstruktion med vinylpläterat stålhus med plastlock i båda ändar.
• Mått: H x B x L = 13 x 13 x 30 cm.
• Vikt: ca 2 kg.
• Termiskt skyddad motor med 183 cm jordledning.
• 5 års begränsad garanti.
• Tillverkas av Vaportek i USA.
ANVÄNDNINGSOMRÅDEN:
• Undersökningsrum
• Sjukhus
• Laboratorier
• Städtjänst
• Rökutrymmen
• Veterinärkliniker
• Tandvård
• Lobbyområden
• Institutioner
• Kapell
• Vårdhem
• Omklädningsrum, sport, industri, etc.
… och många fler.
18, DK-6400 Sønderborg Tel. +45 7442 6292 Info@nac-europe.com www.nac-europe.com

Tips: Använd ECOZ våtluktsanering i tvätt-/ sköljvattnet när du rengör brandskador.





Original Neutrox Gamma Bricks har inte utan anledning blivit en "måste ha" produkt inom den globala skadeservicebranschen. Det finns många bra anledningar till detta!
Vaporteks patenterade och unika luktbehandlingssystem sätter, över hela världen, standarden för miljövänlig och användarvänlig luktsanering inom skadeservicebranschen. En vetenskapligt formulerad komposition med över 30 olika växtextrakt utgör grunden för Vaporteks produktsortiment. Oljan kallas Neutrox Gamma och utvecklades ursprungligen för säker och miljövänlig neutralisering av dålig lukt inom sjukvården.
Neutrox Gamma Bricks släpper ut en ofarlig torrånga baserad på oljor extraherade från aromatiska växter. Torrångan innehåller en komplex sammansättning av över 30 olika naturliga växtextrakt. Torrångan sprider sig snabbt i luften för att omedelbart, på molekylär nivå, inkapsla och neutralisera dålig lukt som härrör från rök- och sotskador, vattenskador, avloppsskador, skadedjur, torrstekning/-kokning, svettning, kemiskt spill, förruttnelse, mögel, fukt, avloppsvatten, avfall, mat, svett, urin, kräkningar, djur etc.
ALLMÄN ANVÄNDNING
Placeras i toaletter, runt soptunnor, under golv, i håligheter, avfallsrum, rökrum, i ventilationskanaler, hängs upp i avfallsschakt (S.C.S, Simple Clip System). Används i dammsugare och för luktsanering vid skadedjursbekämpning.
Art.nr. 56-1397 – Kartong med 4 x 30 st. packade i plastburkar.

SIDAN 40-45
Placera en eller flera Neutrox Gamma Bricks i områden som plågas av lukt efter brand, vattenskador etc. Neutrox Gamma Bricks används framgångsrikt vid avfuktnings-, luftrenings- och ventilationsutrustning för att kontrollera lukt i samband med vatten- och brandskador, etc. Placera Bricks där luft kan passera och absorbera aktiv Neutrox Gamma-olja.









Original Neutrox Gamma Bricks har inte utan anledning blivit en "måste ha"-produkt inom den globala skadeservicebranschen. Det finns många bra anledningar till detta!

Neutrox Gamma Bricks används framgångsrikt vid avfuktning, luftrening och ventilationsutrustning för att kontrollera lukt i samband med vatten- och brandskador.
Placera Neutrox Gamma Bricks där luft kan passera och absorbera aktiv
Neutrox Gamma-olja som omvandlas till luktneutraliserande torrånga.

Kondensavfuktare


Adsorptions-

SOS-oljan är vetenskapligt utvecklad för luktsanering och innehåller en genialisk blandning av specialoljor som fungerar särskilt bra efter alla typer av brandskador.
Placera SOS Bricks i dina avfuktare och ventilationsutrustning etc. för full effekt. Läs mer om SOS-oljan på sidan 37.



AROMA BRICKS – NYTT POPULÄRT ALTERNATIV TILL ORIGINAL NEUTROX GAMMA BRICKS
Innehåller sensationella doftoljor av hög kvalitet som sprider leenden och ger nöjda kunder.
Vaporteks patenterade och unika luktbehandlingssystem sätter, över hela världen, standarden för miljövänlig och användarvänlig luktsanering inom skadeservicebranschen.
En vetenskapligt formulerad sammansättning av växtextrakt utgör grunden för Vaporteks produktsortiment.
Vaportek Aroma Bricks är ett komplement till de välkända och inom skadeserviceindustrin mycket populära Neutrox Gamma Bricks, som är baserad på över 30 naturliga eteriska oljor.
Aroma Bricks finns i ett antal utsökta dofter som glädjer sinnena och som bidrar positivt till att neutralisera lukt eller undertrycka den psykologiska kvarvarande lukt som uppstår i samband med olika försäkringsskador, såsom lukt efter brand, avlopps- och mögelskador och liknande eller bara lägger till en doft i en scen som gör människor glada!
Aroma Bricks från Vaportek består uteslutande av eteriska oljor av hög kvalitet och speciellt utvalda parfymer. Aroma Bricks fungerar precis som våra berömda Neutrox Gamma Bricks. Den utsökta blandningen av fina eteriska oljor och dofter är mättad i en liten rektangulär brick gjord av mycket absorberande cellulosafiber.
Bricks fungerar som ett membran – så när luft passerar över en Brick, frigörs oljorna som små luftburna doftmolekyler och berikar den omgivande luften med en doft som uppfattas positivt av människorna som vistas i rummen.
Neutrox Gamma Bricks – Använd din fantasi – Kan användas överallt där dålig lukt är ett problem.
Vaportek Aroma Bricks är ett populärt tillskott till de välkända och allmänt använda Neutrox Gamma Bricks inom skadeservicebranschen.
Aroma Bricks sprider högkvalitativ doft som gör dina kunder nöjda och som de kommer ihåg dig för.












AROMA BRICKS FINNS I FÖLJANDE AROMER:
56-1707 Vaportek Summer Orange Bricks
56-1708 Vaportek Lemon Bricks
56-1750 Vaportek Cool Green Bricks
56-1730 Vaportek Berry Bricks (Bär)
56-1948 Vaportek Ocean Bricks
56-1954 Vaportek Linen Bricks
Låda med 4 x 30 st. förpackad i plastburkar (kan blandas efter behov).









AROMA BRICKS – NYTT POPULÄRT ALTERNATIV TILL ORIGINAL NEUTROX GAMMA BRICKS
Innehåller sensationella doftoljor av hög kvalitet som sprider leenden och ger nöjda kunder.
SKADESERVICE
Placera en eller flera Aroma Bricks i områden som lider av lukt efter brand, avloppsskador, mögelangrepp etc. Placera Aroma Bricks i kondensatavfuktare, adsorptionsavfuktare, centrifugal el. axiella fläktar eller någon annan typ av luftfläkt. Placera Aroma Bricks i din dammsugare eller direkt i ventilationssystemet och andra områden med god ventilation. Använd Aroma Bricks i torkrum för lösöre som kläder, möbler, teknisk utrustning etc. eller i särskilt luktsaneringsrum. Lägg till exempel Aroma Bricks i stora påsar tillsammans med illaluktande personliga tillhörigheter och liknande.
ANVÄNDNINGSOMRÅDEN:
• På toaletter
• Runt avfallsbehållare/i avfallsrum
• Placeras i moloker
• I ventilationskanaler
• Hängd i Vaportek krokodilnäbb (S.C.S, Simple Clip System).
• Använd din fantasi. Neutrox Gamma Bricks och Aroma Bricks kan användas var som helst och ger omedelbart bra resultat.
Precis som Neutrox Gamma Bricks kan Aroma Bricks användas framgångsrikt vid avfuktning, luftrening och ventilationsutrustning för att kontrollera lukt i samband med vatten- och brandskador etc. Placera Aroma Bricks där luft kan passera och absorbera aktiva oljor från Aroma Bricks. Prova de energiskapande och uppfriskande Aroma Bricks Lemon och Summer Orange
FRESH & CLEAN CITRUS CON CEPT


TIPS & TRICKS FÖR POPULÄRA APPLIKATIONER
SIDAN 40-45
En del av Vaportek "Fresh & Clean Citrus Concept"
RESULTAT = SNABBT, ENKELT, EFFEKTIVT OCH EKONOMISKT ATT ANVÄNDA




INGEN SLÅR KVALITETEN OCH EFFEKTIVITETEN HOS DE SENSATIONELLA ECOZDOFTERNA. VÅRA KUNDER ÄLSKAR NÄR DET FINNS ECOZ-DOFT I LUFTEN.

ECOZ VATTENBLANDBART LUKTBEHANDLINGSKONCENTRAT
ECOZ är speciellt utvecklat för kommersiell och institutionell användning för behandling av lukt på golv, väggar och många andra ytor. När du tvättar kläder och textilier i industriella tvättmaskiner läggs ECOZ Linen till i den sista sköljvattnet för att avlägsna rök och annan lukt. Säkra och effektiva produktrecept, som innehåller naturliga ingredienser, gör ECOZ-vätskor till det önskade valet bland professionella rengöringsföretag etc.
FUNKTIONER OCH FÖRDELAR
ECOZ vattenblandbart luktneutraliseringskoncentrat använder innovativ växtbaserad teknik för att uppfylla kraven för luktkontroll i golvvård samt många andra rengöringsuppgifter. Ingredienserna är baserade på naturliga eteriska oljor som neutraliserar dålig lukt istället för att bara maskera med kemiska/syntetiska dofter. Detta är en av anledningarna till att Vaporteks teknik föredras av yrkesverksamma inom skadeservicebranschen, städbranschen, som en säker och effektiv metod för att lösa kvalitetsproblem kring inomhuslukt.
ECOZ giftfria luktneutraliseringskoncentrat är utformade för att förbättra rengöringsuppgifter av alla slag. ECOZ tillsätts direkt i tvätt- eller sköljvattnet. ECOZ är 100 % kompatibelt med rengöringsprodukter och kan tillsättas i alla typer av luktneutral såpa/ rengöringsmedel. ECOZ är perfekt för användning i sköljvatten, i mattor och textilrengöringsmaskiner samt i alla typer av golvvårdsapplikationer. ECOZ-produkter innehåller 100 % naturliga, doftande eteriska oljor och bryter naturligt ner ett brett spektrum av olika lukter.
SE BESKRIVNING AV VARJE ECOZ-AROMKONCENTRAT PÅ SIDAN 46 UNDER TIPS & TRICKS





REKOMMENDERAD PRODUKTANVÄNDNING:

Textil- och mattrengöringsmaskiner, industriella tvättmaskiner, golvtvättmaskiner, allmän golvtvätt, rengöring av urinoarer och toaletter, toalettgolv, mötesutrymmen, köksgolv, transportabla toaletter, rengöring av väggar, tak etc. efter sot- och brandskador, avfallsområden och många andra applikationer.
ECOZ lämnar en behaglig, långvarig arom i luften.
REKOMMENDERAD DOSERING
Normalt ca 20-100 ml per 10 liter tvätt- eller sköljvatten, dock beroende på typ av lukt och luktintensitet.
NOTERA – ECOZ-produkter är koncentrat. Använd därför alltid rätt blandningsförhållande och använd aldrig produkten koncentrerad.
ECOZ finns i dofterna Classic Neutral, SOS, Lemon, Summer Orange och Linen. Den är speciellt utvecklad för kommersiell och institutionell användning för behandling av lukt på golv, väggar och andra vattentäta ytor. ECOZ är utformad för att kontrollera/neutralisera obehaglig lukt under rengöringsuppgifter av alla slag. ECOZ är 100 % kompatibelt med doftneutrala rengöringskoncentrat och kan enkelt tillsättas till dessa rengöringslösningar. Dofterna (eteriska oljor) sönderdelas inte vid höga temperaturer, produkten skummar inte och har ett neutralt pH-värde. ECOZ kan också appliceras på ytor med kallfoggning, pumpsprutor etc. ECOZ kan användas på såväl porösa som icke-porösa ytor, vid rengöring av golv, väggar, mattor, textilier och tvätt samt som en allmän rums uppfräschare etc.
Biologiskt nedbrytbar. Icke giftigt, ej frätande.
Innehåller 100 % eteriska oljor. Fläckar inte, fettar inte.
Tar bort ett brett spektrum av lukt. Extremt mångsidig applikation.
Finns i 1, 5, 20, 208 liter.
Finns i följande aromer: SOS (Smoke Odour Solution) Lemon, Summer Orange, Classic Neutral och Linen.






ECOZ VATTENBLANDBART KONCENTRAT FÖR LUKTBEHANDLING HAR
OBEGRÄNSADE MÖJLIGHETER - TAR BORT ALLA TYPER AV LUKT!
ALLMÄNNA ANVISNINGAR FÖR ANVÄNDNING/DOSERING ECOZ kan doseras i förhållandet 1:5 upp till 1:128. 20-100 ml ECOZ per 10 liter sköljvatten är standarddosen för dessa effektiva luktneutraliseringskoncentrat i skadeservicebranschen. Högre koncentrationer kan användas om en starkare arom önskas eller om produkten används som rumsuppfräschare. ECOZ kan också användas i kallfoggning, NAC Power Sprayers eller pumpsprutor etc. Det rekommenderas att använda ECOZ Linen i rengöringsmaskiner/tvättmaskiner. När ECOZ används i tvättmaskiner för att avlägsna lukt i textilier, tillsätt ca 10-80 ml till sista sköljvattnet. Alla 5 dofterna kan användas för tvätt och luktbehandling av lös egendom efter brandskador, mögelskador, vattenskador etc.
ECOZ SOS (Smoke Odour Solution) är särskilt effektivt i samband med luktneutralisering för alla typer av rök- och sotskador. Uppnå optimal neutralisering av alla typer av röklukt och undvik luktförvirring genom att använda ECOZ SOS luktneutraliseringskoncentrat i ditt sköljvatten tillsammans med SOS-membran och patroner i Vaporteks effektiva luktneutralisatorer, Restorator och VaporShark. Vi kallar detta system för synergistisk luktkontroll™. Använd också ECOZ Classic Neutral med Neutrox Gamma-olja i membran och patroner som ett alternativ till SOS-systemet. ECOZ Classic Neutral och Neutrox Gamma-olja är allmänt tillämpliga på alla typer av lukt. Produkterna kan användas tillsammans, men också separat, om luktreningsuppgiften inte är av extrem natur. ECOZ Lemon kan också användas i sköljvatten för rengöring efter brand etc. eftersom ECOZ Lemon är kompatibel med torrånga från Neutrox Gamma- och SOS-olja.
FÖR LÄTT RÖKLUKT tillsätt vanligtvis 20-50 ml per 10 liter vatten.
FÖR MÅTTLIG RÖKLUKT tillsätt 20-50 ml per 10 liter vatten.
FÖR KRAFTIG RÖKLUKT tillsätt 20-50 ml per 10 liter vatten.
Vi hänvisar också till produktetiketten.

• Effektiv deodorant för att tvätta ner sot vid brandskador.
• Rengöringsmaskiner för textil/matta.
• I tvätt och moppvatten.
• Hotellrum.
• Rengöring av toaletter/pissoarer.
• Transportabla toaletter.
• Djursjukhus.
• Avfallsområden.
• Toalettgolv.
• Tvättmaskiner.
• Rökrum ... och många fler.




FÖRPACKNINGSSTORLEKAR OCH ART.NR.:
1 LITER - 12 STK. PER LÅDA
56-1524-1 Classic Neutral
56-1521-1 SOS
56-1526-1 Lemon
56-1527-1 Summer Orange
56-1525-1 Linen
5 LITER - 4 STK. PER LÅDA
56-1524-5 Classic Neutral
56-1521-5 SOS
56-1526-5 Lemon
56-1527-5 Summer Orange
56-1525-5 Linen

20 LITER - STYCKEVIS
56-1524-20 Classic Neutral
56-1521-20 SOS
56-1526-20 Lemon
56-1527-20 Summer Orange
56-1525-20 Linen
208 LITER - STYCKEVIS
56-1524-208 Classic Neutral
56-1521-208 SOS
56-1526-208 Lemon
56-1527-208 Summer Orange
56-1525-208 Linen Made by Vaportek

BIO-ENZYMATISK RENGÖRING OCH LUKTSANERING
Specialprodukt från Vaportek, bestående av en komplex blandning av över 30 olika eteriska oljor (100 % naturliga växtextrakt) samt en suspension av mikroorganismer och enzymer.
BIO-C VÄTSKEKONCENTRAT FÖR ORGANISK LUKTNEUTRALISERING
Innehåller eteriska oljor, enzymer och ofarliga bakteriekulturer. Vaporteks unika produktserie av Bio-C vattenblandbar vätskekoncentration eliminerar snabbt, säkert och ekonomiskt alla typer av lukter av organiskt ursprung på platsen.
Bio-C förhindrar igensättning av rörledningar och tränger igenom illaluktande fläckar och missfärgningar av organiskt ursprung på plattor och i fogar i toaletter, pissoarer, badrum etc.
ANVÄNDNING – SKADESERVICE
Bio-C är den perfekta produkten för biologisk neutralisering och nedbrytning av all lukt som härrör från vatten- och avlopps-skador (avföring), fukt- och mögelskador, urin, kroppsvätskor i samband med liksanering, kräkningar, svett, förruttnelse, djur, cigarettrök etc.
Bio-Cs formel är unik och består av miljontals ofarliga bakteriekulturer, enzymer samt Vaporteks speciella blandning av mer än 30 eteriska oljor (100 % naturliga växtextrakt).
Dessa egenskaper gör Bio-C till det suveräna valet när du vill ta bort och kontrollera lukt samt bryta ner organisk förorening och avlagringar.
SKADESANERING
För nedbrytning och neutralisering av lukt som uppstår i samband med vatten- och avloppsskador, liksom lukt av allt annat biologiskt ursprung.
ANDRA APPLIKATIONER
• Behandling av avlopp/kloak.
• Toaletter/pissoarer/badrum/omklädningsrum etc.
• I och runt avfallsbehållare, containrar etc.
• Droppsystem.
• Avfallsbehandlingsanläggning.
• Transportabla toaletter, toaletter etc.
• Avlägsnande av lukt i mattor och andra textilier.
BIO-C TAR BORT
BIOLOGISK/ ORGANISK LUKT


Bio-C främjar och påskyndar den naturliga organiska nedbrytningsprocessen genom att använda en kraftfull blandning av speciella bakteriekulturer samt en stabiliserad komposition av lipas-, cellulas-, proteas- och amylasenzymer.
Bio-C kan användas i de flesta industriella miljöer där lukt önskas avlägsnas och är särskilt effektivt för att ta bort lukt i fettavskiljare, avfallsområden, avlopp och septiska system.
FÖRFARANDEN
Spraya direkt på luktkällan med handspruta, tryckspruta, NAC Power Sprayers eller specialpump/munstyckssystem. Rikta Bio-C direkt i avlopp/fettlås etc. med doseringspumpar. Kontakta NAC för mer information om doseringssystem.
TAR BORT/BRYTER NER LUKT FRÅN
Urin/avföring, organiskt hushållsavfall, sjukhusavfall, rök, avlopp, fettfällor, förruttnelse, kräkningar, fukt, mögel, svett, djur, blod, mjölk, olja och alla andra lukter av organiskt ursprung.
BIO-ENZYMATISK RENGÖRING OCH LUKTSANERING






BIO-ENZYMATISK RENGÖRING OCH LUKTSANERING
Specialprodukt från Vaportek, bestående av en komplex blandning av över 30 olika eteriska oljor (100 % naturliga växtextrakt) samt en suspension av mikroorganismer och enzymer.
SPECIFIKATIONER:
• Vattenblandbart koncentrat.
• Hållbarhet ca 12 månader.
• Ej brandfarligt och frätande.
• Fungerar omedelbart vid kontakt och under lång tid efter applicering.
• Blandningsförhållande: Kan användas koncentrerat och upp till 1:150 (vid normal användning med t.ex. pumpspruta rekommenderad 1:20).
• Multienzymatisk.
• Innehåller ofarliga bakteriekulturer.
• Innehåller Vaporteks unika och ofarliga tillsats av luktneutralisering (eteriska oljor).
• Tål inte frost.
• Biologiskt nedbrytbart.
• Förpackningsstorlekar:
1 liter, 5 liter, 20 liter och 208 liter.
BIO-C:
56-1523-1 Bio-C - 1 liter
56-1523-5 Bio-C - 5 liter
56-1523-20 Bio-C - 20 liter
56-1523-208 Bio-C - 208 liter
2 AKTIVA LÄGEN GÖR BIO-C TILL ETT SUVERÄNT VAL
1 När växtextrakten kommer i kontakt med lukten, kommer vegetabiliska oljemolekyler att reagera med luktmolekylen genom att inkapsla och neutralisera den. Processen fungerar omedelbart och är inte en mask av dålig lukt utan en verklig luktneutralisering.
2 Bio-C innehåller en avancerad suspension av ofarliga bakteriekulturer samt enzymer som bryter ner illaluktande organiskt material och omvandlar de organiska ämnena till vatten och koldioxid. Källan till dålig lukt avlägsnas således permanent.

BIO-C TAR BORT
BIOLOGISK/ORGANISK LUKT
ANVÄNDNINGSOMRÅDEN:
• Skadeservice
• Sjukhus och vårdhem

• Skolor, sport- och idrottsanläggningar
• Bostadsrättsföreningar
• Slakterier
• Skadedjur
• Rensningsanläggningar
• Benmjölsfabriker, fiskeindustri etc.
• Hotell- och restaurangbranschen etc.






SPECIELLT UTVECKLAD FÖR ANVÄNDNING I VENTILATIONSSYSTEM, AVFUKTNINGS- OCH TORKNINGSSYSTEM, FRAMFÖR LUFTFLÄKTAR ETC.
Justerbart aluminiumlock för dosering av torrånga (i båda ändarna av patronen)
Stativ som håller patronen i den önskade positionen
Stativ, der holder patronen i den ønskede stilling
LUKTKONTROLL VID STÖRRE SKADOR

Öppningar för luftflöde
Åbninger til luftgennemstrømning

neutrox gamma oil


HDS-PATRONER FINNS I FÖLGANDE AROMER:
Varenr. 56-1353 HDS patron Neutrox Gamma standard
Varenr. 90-2200-85 HDS patron m. SOS olja
Varenr. 90-2200-86 HDS patron m. Lemon
SPECIFIKATIONER
Placera HDS-patronen i ventilations systemet eller framför luftfläktar/fläktar, som första hjälpen för luktproblem/luktbesvär efter en brand på grund av större skador som t.ex. i varuhus, köpcentra, fabriks-hallar etc.

Placera t.ex. HDS-patroner i större adsorptionsavfuktare för luktkontroll
Förpackningsstorlek: Låda med 6 st.
Mått: 14,6 cm i höjd x 9,5 cm i diameter. Effektiv i upp till 8 veckor vid normal användning. Behandlar ytor upp till 1800 m².
Justerbart aluminiumlock säkerställer exakt dosering av deodoriserande torrånga.
Tillbehör: Återanvändbar patronstabilisator, nr. 90-2201.




I VENTILATIONSSYSTEM, AVFUKTNINGS- OCH TORKNINGSSYSTEM, FRAMFÖR LUFTFLÄKTAR ETC.
ÄNDAMÅL
Vaporteks HDS patron är utformad för att ge passiv luktavhjälpning speciellt för användning i luftkonditionerings-/ventilationssystem. Den används i högpresterande avfuktnings-, luftrenings- och torkningssystem i samband med skadesaneringsarbete efter vatten- och brandskador. Patronen innehåller en patenterad membrantyp som frigör en ofarlig, luktneutraliserande torrånga baserat på en avancerad blandning av över 30 olika växtoljor. Vaportek har använt denna formel för luktavhjälpande inom skadeserviceindustrin, luktkontroll inom livsmedelsproduktion, avfallshantering, sjukvård, på kontor, fabriker, hotell och i privata hem runt om i världen i mer än 45 år.
PLACERING
Den fristående patronen kan placeras i vilket luftbehandlingssystem som helst. För maximal effekt, placera patronen i längdriktningen och öppna de justerbara locken i ändarna helt eller delvis så att luft passerar genom patronen. Patronen kan hållas på plats med ett stativ. När luftströmmarna är mycket starka kan patronen fästas med tejp eller dubbelsidig tejp. Patronen kan också placeras framför luftfläktar/fläktar och liknande för att uppnå en snabb och effektiv luktsanering, till exempel efter brandskador eller i samband med mattrengöring och liknande.
FÖRDELAR OCH FUNKTIONER
Vaporteks HDS patron ger omedelbar och kraftfull luktkontroll i områden där de flesta andra system inte klarar det. Den luktborttagande torrångan tränger snabbt in i de porösa ytorna den kommer i kontakt med.


AKUT LUKTKONTROLL
Stativet används för att hålla patronen i önskat läge. Vrid patronens justerbara ändstycken till önskat läge och sätt in patronen horisontellt i stativet. Placera patronen/stativet i en luftkanal eller framför ett luftspjäll där luft kan flöda genom patronen.

LUKTSANERING OCH TORKNING SAMTIDIGT VID BRAND- OCH VATTENSKADOR
Genom att placera den fristående patronen i ett stativ som du sedan ansluter till en luftfläkt/fläkt, producerar du både aktiv torrånga för att ta bort lukt och luft för torkning efter vatten- och brandskador.
LUGTSANERING OCH TORKNING SAMTIDIGT.









Sedan Vaportek grundades 1979 har företagets unika Neutrox Gamma Oil varit ryggraden i företagets globala framgång och den vetenskapligt komplexa blandningen av komplexa naturliga oljor har ännu inte kopierats, helt enkelt för att det inte är möjligt!
Vaportek-tekniken är en unik metod för säker, effektiv och enkel luktborttagning. Metoden har, över hela världen, satt en ny standard för miljö- och användarvänlig luktsanering inom skadeserviceindustrin.
En vetenskapligt formulerad och patenterad komposition med mer än 30 olika och 100 % naturliga aromatiska växtextrakt utgör grunden för Vaporteks mångsidiga produktsortiment. Denna komplexa blandning av eteriska oljor kallas Neutrox Gamma och utvecklades i slutet av 70-talet av en ansedd amerikansk läkemedelsproducent för att på ett säkert och effektivt sätt neutralisera lukt i den amerikanska sjukvården. Idag används Vaportek med stor framgång i många olika branscher och industrigrenar.
Neutrox Gamma-oljan är hermetiskt innesluten i ett speciellt plastmembran. När luft passerar över membranet, med hjälp av Vaportek-enhetens inbyggda fläkt, diffunderar oljan genom membranet och släpps ut i luften som en aktiv torrånga. De vegetabiliska molekylerna från från torrånga är extremt aktiva och sprider sig snabbt till hela behandlingsområdet och tränger effektivt in i porösa ytor såsom trä, betong, tapeter, gips, tegel, textilier etc. och sätter sig på icke-porösa ytor för att snabbt och effektivt inkapsla och neutralisera eller luktmodifiera luktproblem från brand och sotskador, nikotin, urin, mögel, avlopp, avföring,



NEUTROX GAMMA FINNS I FÖLJANDE VERSIONER:
torrstekning/torrkokning, svett, kräkningar, matos, förruttnelse, husdjur och alla andra lukter av organiskt ursprung.
DENNA NEUTRALISERINGSPROCESS KALLAS "ZWAARDEMAKER PAIRS"
Intensiv forskning om de unika eteriska oljorna, som också används för utveckling av medicin, har visat att många av dessa oljor har förmågan att neutralisera lukt om du parar ihop/kombinerar en eterisk olja med en viss lukt.
Formeln för Vaporteks komplexa blandning av dessa oljor är noggrant sammansatt baserat på det faktum att speciellt utvalda eteriska oljor neutraliserar lukt av olika ursprung.
Se sidorna 16-18 för en mer detaljerad förklaring av hur eteriska oljor neutraliserar lukt enligt Zwaardemaker Pairs-metoden.
Tillsammans med Neutrox Gamma-oljan i membranet/patronen rekommenderar vi att du använder ECOZ-luktsaneringskoncentrat Classic Neutral, Lemon eller Summer Orange.












Vaportek – Obegränsade möjligheter – Tar bort alla slags lukter!
SOS-oljan är vetenskapligt utvecklad för att neutralisera lukt efter brand och rökskador. Vaportek erbjuder denna geniala blandning av eteriska oljor som ett alternativ till den ursprungliga och populära Neutrox Gamma-oljan. SOS doften är trevlig, men ändå kraftfull och effektiv, vilket gör den till ett idealiskt val för att neutralisera röklukt i privata hem såväl som andra områden där människor bor, samtidigt som arbetsmiljön förbättras för skadesaneringsarbetarna. SOS är inte en ersättning för Neutrox Gamma-olja, men bör ses som ett effektivt alternativ för alla typer av rök- och sotskador. SOS-oljan finns som membran för VaporShark, som en patron för Restorator och som en HDS patron för t.ex. luktbehandling av ventilationskanaler.
Se sidorna 16-18 för en mer detaljerad förklaring av hur eteriska oljor neutraliserar lukt enligt Zwaardemaker Pairs-metoden.
"Vi använder SOS-olja med stor framgång vid alla typer av bränder. Skadade parter är mycket nöjda och alla uppskattar den milda aromen som SOS-oljan ger."
Allan Nielsen, avdelningschef - Polygon A/S, Struer


SOS FINNS I FÖLJANDE VERSIONER:
56-1521-1 ECOZ våtluktsanering – SOS
56-1766 SOS Membran för VaporShark


56-1769 SOS Restorator patron för Restorator 90-2200-85 SOS HDS patron
56-1709 SOS Bricks
PERFEKT FÖR:
Proteinbränder
Eld i gryta/stekpanna, bränt och förkolnat kött och de flesta bränder som involverar cellvävnad och hårproteiner.
Trä-/papperbränder
Brand i tak, skorstensbrand, explosionsbrand och brand i byggnader och i allmänhet där träkonstruktioner är inblandade etc.
Syntetiska bränder
Mattor och stoppade möbler, eld i elektriska installationer och i allmänhet där plast bränns.
Cigarettrök/Nikotinlukt
Privata hem, lägenheter, restauranger, väntrum, fordon och överallt där tobaksrök är ett problem.
Tillsammans med Neutrox Gamma-oljan i membranet/patronen rekommenderar vi att du använder ECOZ-luktsaneringskoncentrat Classic Neutral, Lemon eller Summer Orange.







Vi hyllar Fresh & Clean Citrus Concept – Vaporteks fantastiska förmåga att formulera produkter som fungerar och gör människor glada. Citrusdofter är förknippade med renhet och friskhet. Speciellt inom skadeserviceindustrin är doften av renhet och friskhet populär! Fresh & Clean Citrus Concept är en säker framgång!
Sedan Vaportek grundades 1979 har företagets unika Neutrox
Gamma olja varit ryggraden i företagets globala framgång och den vetenskapligt komplexa blandningen av komplexa naturliga oljor har ännu inte kopierats, helt enkelt för att det inte är möjligt. Tillsammans med den liknande vetenskapligt formulerade SOS-oljan (Smoke Odour Solution) är dessa 2 oljor populära inom skadeserviceindustrin och skapar övertygande resultat när envis lukt efter brand och andra illaluktande skador måste kontrolleras och neutraliseras.
Som ett friskt och doftande initiativ hyllar Vaportek i sitt Fresh & Clean Citrus Concept doften av de ständigt populära citrusfrukterna. Fresh & Clean Citrus Concept finns i en Lemon-version och en Summer Orange-version.
Den populära Vaportek Lemon-doften har alltid varit en av våra bästsäljare. Lemon- och Summer Orange-versionerna finns som membran för VaporShark, patroner för Restorator, som Aroma Bricks och som koncentrerade ECOZ-luktbehandlings-koncentrat.
ANVÄNDNING AV LEMON MEMBRAN OCH PATRONER I VAPORSHARK OCH RESTORATOR
ECOZ Lemon har i flera år varit en av våra bästsäljare bland ECOZ-produkter, men också som membran och Aroma Bricks, helt enkelt för att Vaporteks Lemon-produkter doftar fantastiskt! Anledningen till den friska, rena och effektiva citrusaromen är helt enkelt användningen av äkta eteriska oljor från flera olika citrusfrukter. ECOZ Lemon kallas på fackspråk för en topnote-doft.
Topnote-dofter är gröna dofter. De är fräscha och baserade på toner från citrusfrukter som citron, bergamott, apelsin, mandarin, grapefrukt etc.
Lemon-membran och patroner används separat för mindre luktskador, där de fräschar upp de behandlade rummen med en naturlig och fascinerande skön, ren och fräsch citrusdoft. Lemon-membran kan också användas i kombination med SOS eller Neutrox Gamma-membran, vid allvarlig luktskada där den primära luktneutraliseringen kommer från Neutrox Gamma- eller SOS-olja, men där Lemon ger en uppfriskande ny touch av underbar citrusdoft, vilket uppskattas av kunderna. Lemon-membran har också en antiseptisk effekt.
NY SUMMER ORANGE – ANVÄNDNING AV SUMMER-ORANGEMEMBRAN OCH PATRONER I VAPORSHARK OCH RESTORATOR Som ett nytt och friskt tillägg och för att berika urvalet av underbara Vaportek-dofter, har Vaportek introducerat en annan härlig, fräsch och doftande toppnot-doft, nämligen Vaportek Summer Orange. Vaportek har framgångsrikt fångat doften av färskpressade apelsiner. Summer Orange membran och patroner är fräscha, bubblande och varma och doften levereras av mandarin, apelsin, blodapelsin, grapefrukt etc.
Varken Lemon- eller Summer-Orange-membran ersätter användningen av Neutrox Gamma eller SOS membran, eftersom dessa är vetenskapligt formulerade för att neutralisera lukt vid professionell skadesanering, men de kan användas i kombination med eller efter avslutad behandling med Neutrox Gamma eller SOS för att lägga till en ny touch av citrusdoft till jobbet som den skadelidande kommer att uppskatta.
Våra kunder älskar Vaporteks citrusprodukter Lemon och Summer Orange, som finns som membran, patroner, Aroma Bricks och ECOZ vätskor. Dessa kan användas individuellt eller i interaktion med varandra, beroende på luktens intensitet. Om några av de mest använda citrusoljorna i ovanstående produkter sägs det:


GRAPEFRUKT: Ger ny energi och gott humör – skärper koncentrationen
CITRON: Ger gott humör och energi – hjälper dig att fokusera
BERGAMOTT: Ger ny energi och har en uppfriskande effekt
APELSIN: Ger ett gott humör och har en uppfriskande effekt
MANDARIN: Ger energi och gott humör

Resultat: Dina kunder kommer att vara glada när de känner den friska fläkten av Lemon eller Summer Orange.




MILJÖVÄNLIG
Vaportek – Obegränsade möjligheter – Tar bort alla slags lukter!
MEMBRANER FÖR VAPORSHARK:
- SOS (Smoke Odour Solution)
- Neutrox Gamma
- Summer Orange
- Lemon
- Se också sidan 21

PATRONER FÖR RESTORATOR:
- SOS (Smoke Odour Solution)
- Neutrox Gamma
- Lemon
- Summer Orange
- Andra varianter:
Se sidan 22










BESTSELLER-PRODUKTER FRÅN VÅRT FRESH & CLEAN CITRUS CONCEPT
Lemon & Summer Orange som ECOZ-koncentrat & Aroma Bricks. Baserat på äkta eteriska oljor för effektiva och doftande resultat som dina kunder kommer att älska! FRÄSCH OCH SÖT

FÅ UT MESTA MÖJLIGA AV DIN VAPORSHARK
Använd Neutrox Gamma eller SOS ensam eller i kombination med ett Lemon- eller Summer Orange-membran.
FÅ UT MESTA MÖJLIGA AV DIN RESTORATOR
Använd Neutrox Gammaeller SOS-patroner eller prova en Lemon- eller Summer Orange-patron från vårt Fresh & Clean Citrus Concept.





FÅ UT MESTA MÖJLIGA AV DINA VAPORTEK-PRODUKTER OCH FÅ NÖJDA KUNDER
VAPORTEK NEUTROX GAMMA BRICKS
Neutrox Gamma Bricks är en av våra bästsäljare för skadeserviceindustrin i Europa.
ANVÄND VID BRAND OCH SOTSKADOR
Alla typer av bränder – brända syntetiska material, proteinbränder (bränt kött), bränt trä och andra byggmaterial etc.
Neutrox Gamma Bricks kan placeras var som helst där lukt efter brand etc. är ett problem. Placera Neutrox Gamma Bricks i särskilt utsatta områden med luktproblem. Ju större luftflöde desto bättre kan Neutrox Gamma Bricks frigöra essentiella växtoljor som en aktiv luktneutraliserande torrånga. Placera därför Neutrox Gamma Bricks på platser med drag eller god luftventilation, även direkt i ventilationskanaler.
Vid luktproblem i större rum, placera en centrifugal-, axial- eller annan luftfläkt i rummet och montera en eller flera Neutrox Gamma Bricks i in- eller utsugssidan, någonstans i fläktens luftflöde eller direkt i kanalpåsen, om sådan finns. Detta kommer att frigöra aktiv Neutrox Gamma torrånga och undertrycka/neutralisera den obehagliga doften av sot/rök.
Du kan eventuellt fästa en Neutrox Gamma Brick i vårt S.C.S (Simple Clip System) och montera S.C.S-kedjan på din luftfläkt, se bild sidan 14.
Vid efterföljande avfuktning av släckvatten kan Neutrox Gamma Bricks monteras i kondens-, adsorptionsavfuktare eller luftblåsare/ventilationsutrustning och liknande för fortsatt och ihållande luktbehandling.
ANVÄND VID VATTEN- OCH AVLOPPSSKADOR
Alla typer av fukt och vattenskador där lukt är ett problem. Avlopp, avloppsvatten, processvatten, biologiskt förorenat vatten, etc.
Neutrox Gamma placeras helt enkelt där lukten av till exempel avlopp eller el. avloppsvatten är ett problem. Om det behövs sprayar du först de förorenade ytorna med Vaportek Bio-C, som bryter ner organiska lukter med hjälp av eteriska oljor, enzymer och mikroorganismer. Placera också Neutrox Gamma Bricks i Vaportek S.C.S (Simple Clip System) och fäst den på din ventilationsutrustning som centrifugal el. axiella fläktar.
Under avfuktningsprocessen kan Neutrox Gamma Bricks monteras i kondens-. adsorptionsavfuktare eller fläkt/ventilationsutrustning och liknande för kontinuerlig och kontinuerlig luktbehandling.
BRICKS FINNS NU OCHSÅ MED

SIDORNA 26-29

ANVÄND VID AVFÖRING, KRÄKNINGAR, URIN, RUTTNAT KÖTT INKLUSIVE LIKLUKT OCH ALLA ANDRA LUKTER AV ORGANISKT URSPRUNG.
Spraya först alla ytor med Vaportek Bio-C, som sönderdelar organisk-biologiska föroreningar och använd Neutrox Gamma Bricks i din luftbehandlingsutrustning och liknande.
AVLÄGSNANDE AV PSYKOLOGISK KVARVARANDE LUKT
I fall där en psykologiskt kvarvarande lukt uppstår efter en fullständig skada kan detta ofta elimineras med hjälp av Neutrox Gamma Bricks eller Aroma Bricks. En psykologisk restlukt är en lukt som endast uppfattas av kunden och som egentligen inte är en lukt i sig. Genom att ge kunden en Neutrox Gamma Brick eller en Aroma Brick kan problemet lösas.
Använd din fantasi och du kommer att upptäcka att Neutrox Gamma Bricks är en superprodukt som ger första hjälpen mot lukt i situationer där det måste gå snabbt. Resultatet är alltid nöjda kunder som snabbt märker och uppskattar att du har gjort något för att ta bort den obehagliga lukten.
NEUTROX GAMMA BRICKS TAR BORT/NEUTRALISERAR
ALLA TYPER AV LUKT!
Neutrox Gamma Bricks innehåller aktiv Neutrox Gamma-olja som avlägsnar/neutraliserar ett mycket brett spektrum av olika lukter som härrör från brand- och sotskador, mögel, avlopp, illaluktande industriellt avloppsvatten, förruttnelse inklusive kroppslukt, organiskt hushållsavfall inklusive lakvatten, kräkningar, urin, svett, skadedjur, husdjur, lukt efter torrstekning/torrkokning och många fler.




NEUTROX GAMMA BRICKS KAN ANVÄNDAS VAR SOM HELST!
Placera Neutrox Gamma Bricks i de medföljande aluminiumbrickorna och sätt upp dem i hem och byggnader för att omedelbart kontrollera lukten. Placera Neutrox Gamma Bricks i kondensavfuktare, adsorptionsavfuktare, kanalfläktar, centrifugalfläktar, axiella fläktar, HEPA-luftrenare och all annan teknisk skadeserviceutrustning som genererar luftströmmar.
Placera Neutrox Gamma Bricks i ventilationskanaler. Placera Neutrox Gamma Bricks på svåråtkomliga platser som under golv,
kryputrymmen, vindar, mellan golv, håligheter etc. Antalet Neutrox Gamma Bricks som du behöver använda för varje uppgift beror på typen av lukt, luktintensitet och rumsvolym.
Det finns inga gränser för var du kan använda den här lilla men extremt effektiva produkten, som ger dig full effekt med aktiv torrånga från Vaportek Neutrox Gamma-olja.

Om du vill berika luften med en mild och underbar doft kan Aroma Bricks användas på exakt samma sätt som Neutrox Gamma Bricks!






Neutrox Gamma Bricks användas framgångsrikt vid avfuktning, luftrening och ventilationsutrustning för att kontrollera lukt i samband med vatten- och brandskador, etc.
Placera Neutrox Gamma Bricks där luft kan passera och absorbera aktiva oljor som omvandlas till luktneutraliserande torrånga.
1 KONDENSAVFUKTARE
Luktkontroll t.ex. i samband med avfuktning av allmänna fukt- och vattenskador samt vattenskador orsakade av släckvatten efter brand.





Placera Neutrox Gamma Bricks eller Aroma Bricks i avfuktarens luftintag eller utlopp.


Kan också placeras i rörpåsar









FÅ UT MESTA MÖJLIGA AV DINA VAPORTEK-PRODUKTER OCH FÅ NÖJDA KUNDER
2 VÄRMETORKNING AV VATTENSKADOR MED DRYMATIC UTRUSTNING





SIDORNA 26-29



Placera Neutrox Gamma eller Aroma Bricks i luftintagsslangen på Drymatic II (bild 1) eller placera dem i golvmattor eller väggtorkning med Drymatic mattor tillsammans med Boost Bar (bild 2).
3 CENTRIFUGAL LUFTFLÄKT
Luktkontroll t.ex. i samband med brand och vattenskador etc.


Kläm fast Neutrox Gamma Bricks eller Aroma Bricks i Vaportek S.C.S (Simple Clip System) och montera det på luftblåsarens luftintag eller utlopp.



4 GOLVFLÄKT
Luktkontroll t.ex. i samband med brand- och vattenskador.


Kläm fast Neutrox Gamma Bricks eller Aroma Bricks i Vaportek S.C.S (Simple Clip System) och montera den på golvfläktens framsida eller baksida.






FÅ UT MESTA MÖJLIGA AV DINA
VAPORTEK-PRODUKTER OCH FÅ NÖJDA KUNDER
5 AXIELL LUFTFLÄKT
Luktkontroll t.ex. i samband med brand och vattenskador etc.






Kläm fast Neutrox Gamma Bricks eller Aroma Bricks i Vaportek S.C.S (Simple Clip System) och montera det på fläkten eller luftutloppet på fläkten. Lägg också Neutrox Gamma eller Aroma Bricks i axiella fläktkanalsäckar.
6 OLIKA APPLIKATIONER
Lite mer inspiration för andra användningsområden.



Placera doftande Lemon eller
Summer Orange
Aroma Bricks i din vakt/ servicebil – dina kunder kommer att märka det.
"Små saker gör stor skillnad". Kom ihåg att luktsinnet är kopplat direkt till hjärnområdet som kallas det limbiska systemet och som styr minne, känslor och instinktivt beteende. Det luktar rent och gott när du har slutfört ditt jobb - det upplevs av kunden som positivt. Det ger ett positivt varumärke för ditt företag, förbättrar din professionella image och stärker därmed din konkurrenskraft. DET ÄR FAKTA.

Använd Neutrox
Gamma Bricks för att ta bort lukt efter skadedjur – spraya först området med Bio-C.

Använd Neutrox
Gamma Bricks eller Aroma Bricks för lukt från husdjur. T.ex. urin, våt hund, avföring etc. Spraya vid behov först med Bio-C.


Använd Neutrox
Gamma eller Aroma Bricks i Lemon eller Summer Orange på ditt avfuktningsjobb och lämna en doft som dina kunder kommer att älska.

Brand i lägenheter orsakar ofta lukt i trapphus.
Placera Neutrox
Gamma Bricks på olika ställen i trapphuset och undvik luktbesvär för grannarna.
Gör dina kunder nöjda. Ge dem en gratis doftande Aroma
Brick i en EZTwist när du är klar med skadan – de kommer ihåg dig för det.
FÅ UT MESTA MÖJLIGA AV DINA VAPORTEK-PRODUKTER OCH FÅ NÖJDA KUNDER
7 HEPA LUFTRENARE
Luktkontroll t.ex. i samband med mögelsanering etc.


Sätt in en Neutrox Gamma Brick eller Aroma Brick i luftintaget eller i luftutloppet.



8 VENTILATIONSKANALER





Kontroll av lukt i ventilationskanaler med luktproblem och/eller luktkontroll i rum som försörjs med luft via ventilationskanalen.
Placera en eller flera Neutrox Gamma Bricks eller placera en Heavy-Duty Stand Alone Cartridge (HDS) i ventilationskanalen. Härmed avlägsnar/kontrollerar du lukt från luftningskanalen och behandlar samtidigt rum som försörjs med luft från samma ventilationskanal.Du använder ventilationskanalen för att sprida aktiv torrånga till flera rum med luktproblem.
















Professionelle støvsugere
FÅ UT MESTA MÖJLIGA AV DINA
VAPORTEK-PRODUKTER OCH FÅ NÖJDA KUNDER
En kendt og respekteret arbejdshest - effektiv og driftssikker til rengøring af store arealer
9 FRÄSCH DOFTNEUTRALISERANDE DOFT VID DAMMSUGNING
Nilfisk VP930 er den pålidelige partner til krævende rengøringsopgaver på
Kontroll av dålig lukt från dammsugare.
hoteller, skoler, kontorer og hospitaler. Robust og stabil med stor støvsugerpose, der rummer 15 liter. Det gennemtænkte design optimerer luftstrømmene og reducerer energitabet til et absolut minimum, samtidig med at det gør VP930 til en af de mest lydsvage professionelle støvsugere i verden. Resultatet er fremragende sugestyrke og imponerende holdbarhed. Det er grunden til, at vores kunder holder sig til VP930 år efter år.
Vid dammsugning i skadeserviceindustrin kan en obehaglig lukt uppstå från dammsugaren. Placera en eller flera Neutrox Gamma Bricks eller Aroma Bricks i dammsugarpåsen, bredvid dammsugarpåsen eller i kombination med HEPA-filtret på luftutloppet.

Meget lavt støjniveau
Enestående holdbarhed med robust stålbeholder
Kvalitetskomponenter

Stor kapacitet med 15 liter støvpose HEPA H13-filter som standard Parkeringsløsning som standard 2 hastigheder på flere modeller
Neutrox Gamma Bricks eller Aroma Bricks förvandlar dålig lukt till en behaglig doft som kommer att uppfattas positivt av din omgivning.
Effektiv luktkontroll – förebyggande i bilar, husbilar, båtar, husvagnar, stugor etc.







Lägg Neutrox Gamma eller Aroma Bricks i skåp, under bilstolar etc. i de medföljande aluminiumskålarna eller dela en Brick i mitten och placera dem i en EZ-Twist. Häng upp med hjälp av kardborrsystemet.


Kombinera 1 Neutrox Gamma Bricks med t.ex. 1 Lemon eller Summer Orange Aroma Brick. Ger en effektfull verkan från Neutrox Gamma Bricks med en fräsch touch av 100 % naturlig citrusdoft. Dina kunder vi älskar det!











SIDORNA 30-31
BESKRIVNING AV ECOZ VÅTLUKTSANERINGSKONCENTRAT. FÅ UT DET MESTA AV VAPORTEK-PRODUKTERNA OCH FÅ NÖJDA KUNDER.
Eteriska oljor av citrusfrukter. Citron, mandarin, apelsin, druva, lime etc. Underbar naturlig doft av färsk citrus. Vår ECOZ Lemon-version är en av våra kunders absoluta favoriter och är en del av det nya "Fresh & Clean Citrus Concept". ECOZ Lemon luktar inte som någon annan syntetiskt producerad citrusdoft. ECOZ Lemon är (koncentrerad) och gjord av 100 % eteriska oljor från utvalda citrusfrukter. ECOZ Lemon är populär både bland sanitetsarbetare och inte minst bland skadelidande som njuter av doften av färska, rena och naturliga citrusfrukter i sina hem.
När det luktar ECOZ Lemon – luktar det RENT.
UNIVERSELL ANVÄNDBAR FÖR LUKTBORTTAGNING OCH FRÄSCHAR UPP LUFTEN UNIVERSAL FÖR LUKTBORTTAGNING OCH FRÄSCHAR UPP LUFTEN
För att berika ECOZ-produkterna med en annan fräsch, naturlig och energiskapande citrusdoft, introducerar vi ECOZ Summer Orange, som tillsammans med ECOZ Lemon bildar NAC:s nya "Fresh & Clean Citrus Concept". Vaportek har framgångsrikt fångat doften av färskpressade apelsiner. ECOZ Summer Orange består av mandarin, apelsin, blodapelsin och grapefrukt, etc. Summer Orange luktar bara fantastiskt, skapar positiv energi, ren luft och gott humör. Använd Summer Orange i sköljvattnet när du tvättar efter brand och avloppsskador etc. för rengöring av möbler, eller lägg ut ECOZ Summer Orange med din kalla fogger och mycket mer. ECOZ Summer Orange är redan en hit bland många kunder. När det luktar ECOZ Summer Orange – luktar det RENT.
FRESH & CLEAN CITRUS CON CEPT

FIN FRÄSCH CITRUSDOFT

FRÄSCH OCH SÖT APELSINDOFT


ECOZ CLASSIC NEUTRAL
LÄMPLIG FÖR ALLA TYPER AV LUKTSKADOR – VÅR KLASSISKA DOFT
Vår ECOZ Classic Neutral är en klassiker och dess styrka och kraft från speciellt utvalda eteriska oljor gör den till ett säkert val för alla luktutmaningar. Classic Neutral, liksom de andra ECOZ-versionerna, är ett kraftfullt koncentrat där du får något för pengarna. ECOZ hanterar allt från brandlukt, liklukt, avloppslukt etc. och misslyckas dig aldrig. Classic Neutrals rena och lätt kryddiga arom består av eukalyptus, mynta och andra doftande eteriska oljor.
Classic Neutral är ett säkert val för alla luktproblem.
LÄMPLIG FÖR NEUTRALISERING AV RÖK- OCH SOTLUKT
Speciellt lämplig för alla typer av trä/papper/protein och syntetiska bränder. En utvald blandning av eteriska oljor för olika brand- och sotskador etc. Fantastisk produkt för att neutralisera rök och sotlukt. Vårt ECOZ SOS är helt enkelt ett genialt och vetenskapligt formulerat koncentrat bestående av utvalda eteriska oljor som reagerar särskilt effektivt på eld och sot. För många kunder en favorit vid rengöring efter brand och sotskador. SOS doftar milt av kanel, citrus och andra spännande doftnyanser. SOS lämnar en mycket trevlig mild doft.
VÄRDEFULL OCH SUPEREFFEKTIV PRODUKT FÖR ATT TA BORT ALLA TYPER AV LUKT I TEXTILIER
Uppskattad och supereffektiv produkt för att ta bort alla typer av lukt i textilier. Lämnar en underbar och mild doft av nytvättade kläder/linne. Lägg ECOZ Linen i tvättmaskinen eller i möbeloch mattrengöringsmaskinen. ECOZ Linen avlägsnar effektivt lukt från eld och rök, mögellukt, svettlukt etc. Linen lämnar en underbar doft av nytvättade kläder/linne.

FÅ ETT GRATIS TESTPAKET
EN KLASSISK ALLROUND

EFFEKTIVT FÖR BRAND- OCH SOTSKADOR

POPULÄR FÖR TVÄTT

LUKTAR BARA BÄST
Vilka ECOZ-produkter ska jag välja? Om du är osäker på ditt val, skaffa ett gratis provpaket med små 250 ml. flaskor, eller blanda en kartong (12 x 1 liter) till introduktionspriset och testa produkterna på dina luktsaneringsuppgifter. DU KOMMER ATT BLI GLAD.




FÅ UT DET MESTA AV VAPORTEK-PRODUKTERNA OCH FÅ NÖJDA KUNDER
VAPORTEK ECOZ
VÅTLUKTSANERINGSKONCENTRAT
ECOZ våtluktsaneringskoncentrater är bland våra mest populära produkter inom professionell skadesanering, och det finns flera orsaker till detta. Nämligen effektivitet och doft som dina kunder bara kommer att älska!
Alla olika ECOZ-versioner består av komplexa eteriska oljor, som är utformade för att neutralisera lukt och lämna en långvarig arom i luften. Om du rengör efter t.ex. en brandskada och om du använder en ECOZ-produkt i sköljvattnet kommer dina ansträngningar att märkas omedelbart eftersom du sprider en positiv doft som din omgivning kommer att älska och märker. Vaporteks ECOZ-produkter är överlägset de mest avancerade, mest koncentrerade och mest doftande luktneutraliseringskoncentraten på den professionella skadeståndsmarknaden, åtminstone tycker våra kunder det.

BESTSELLER SKADESERVICE






Lukten av rök och sot efter en brand väcker dåliga känslor hos den skadade, men så snart du börjar rengöra efter en brand eller vattenskada och använder en ECOZ-produkt blir frustrationen till ett leende! ECOZ-produkter doftar inte bara gott, de tar också bort lukt effektivt.
Vid tvätt/rengöring efter brännskador används ofta två hinkar: en hink med doftneutral alkalisk rengöringsvätska och en hink med rent sköljvatten. Vi rekommenderar att du tillsätter 20-100 ml ECOZ-koncentrat per 10 liter sköljvatten, dock beroende på typ av lukt och luktintensitet.
Lukt av rök/sot som finns på ytan neutraliseras oftast av sköljvattnet när en lämplig ECOZ-produkt tillsätts. De extremt små molekylerna av eteriska oljor tränger in i ytan och neutraliserar lukten enligt Zwaardemaker Pairs-metoden. Ytan verkar ren, luktfri och utan fettrester med en touch av ECOZ-doft. Efterföljande ytbehandling i form av färg kan utföras utan problem.
För stark, medium och mild rök/sotlukt använd ECOZ SOS eller Classic Neutral – för mildare lukt använd ECOZ Lemon eller Summer Orange. Om det behövs kan du sedan använda en Restorator eller VaporShark med membran/patroner som innehåller samma arom som ECOZ-produkterna. Vi kallar det synergistisk luktkontroll. Se produktdatablad på sidan 31 för mer information.

1
Rengöringsvatten med alkaliskt rengöringsmedel


Sköljvatten med ECOZ-koncentrat + 2

ECOZ-KONCENTRAT OCH ULV-KALLFOGGER
ECOZ-produkter är också populära att använda i ULV-kallfogger. Späd alltid ECOZ-produkterna med vatten och i rätt blandningsförhållande. Använd ECOZ i ULV-kallfogger för luktbehandling i byggnader och rum efter brand- och rökskador på ventilationskanaler, kryputrymmen, släpvagnar etc. Använd aldrig ECOZ koncentrerad!








ECOZ våtluktsaneringskoncentrater och andra kemikalier från NAC appliceras lekande lätt med en Power Sprayer. NAC Power Spray-serien består av en rad professionella elektriska sprutor som använder hållbara magnetiska pumpar som ger extremt god tillförlitlighet, konstant tryck med perfekta och enhetliga spraymönster. De elektriska sprutorna är som skapade för skadeserviceindustrin och säkerställer snabba och optimala resultat med alla NACs kemiska produkter. Hos NAC Europe vet vi att det är en viktig motiverande faktor för alla anställda inom skadesaneringsarbetet att arbeta med verktyg som gör påföringsprocessen enkel, snabb och effektiv och därigenom skapar jobbnöjdhet och uppnår de bästa och mest lönsamma resultaten. Som man säger "Bra verktyg är hälften av arbetet".













FÅ UT DET MESTA AV VAPORTEK-PRODUKTERNA OCH FÅ NÖJDA KUNDER
ECOZ-koncentrater är populära i hanteringen av lösöre. Tillsätt ECOZ Lemon, Summer Orange eller Classic Neutral till tvätt- eller sköljvattnet när du tvättar/rengör alla typer av lösöre som tål vatten, såsom porslin, dockor, hantverk, dekorativ heminredning, keramik, lampor, hushållsapparater, vitvaror etc.
Lösöre som lämnas tillbaka till den skadelidande får inte lukta av sot/rök, använd därför Vaporteks doftande och effektiva ECOZ-produkter för att ta bort lukt och ge en doft till föremålet som den skadelidande garanterat kommer att njuta av. Nöjda kunder betyder allt.



5 LUKTSANERING AV TEXTILIER EFTER BRANDSKADOR ETC.
Tillsätt ECOZ Linen i din tvättmaskin. ECOZ Linen avlägsnar effektivt rök och sotlukt och lämnar en underbar doft. Om du vill ha en luktborttagare för kläder utan doft/eteriska oljor rekommenderar vi vårt nya och revolutionerande OdorKlenz Laundry Additive som neutraliserar och avlägsnar all lukt och kemikalier från alla tvättbara textilier med naturens egna jordmineraler. Patenterad. ECOZ Linen och OdorKlenz är marknadens bästa lösningar för luktbehandling av textilier. Vi rekommenderar att produkterna används separat.



6 LUKTSANERING AV MATTOR, STOPPADE MÖBLER ETC.
Efter brand och andra luktskador. Lägg till lite ECOZ Linen, Classic Neutral, Summer Orange eller Lemon i sköljvattentanken i din matt- och möbelrengörings maskin. Dina mattor och möbler blir fria från lukt och luktar bra igen.





FÅ UT DET MESTA AV VAPORTEK-PRODUKTERNA OCH FÅ NÖJDA KUNDER
Den komplexa blandningen av olika eteriska oljor, liksom innehållet i speciellt utvalda mikroorganismer och enzymer, bidrar till en snabb och fullständig nedbrytning av lukt relaterad till skador av biologiskt/organiskt ursprung. T.ex. lukt från avlopp, avföring, lik, organiskt hushållsavfall, urin, skadedjur, kräkningar etc.
Applicera Bio-C på alla förorenade ytor med vattenkanna, ULV-kallfogger, NAC Power Sprayers, trycksprutor etc. Eller tillsätt Bio-C i fettfällor, avlopp och liknande med doseringspumpar/teknik. Kontakta NAC angående tekniska frågor rörande doseringsteknik.
1 När växtextrakten kommer i kontakt med lukten, kommer vegetabiliska oljemolekyler att reagera med luktmolekylen genom att inkapsla och neutralisera den. Processen fungerar omedelbart och är inte en maskering av dålig lukt utan en verklig luktneutralisering.
2 Bio-C innehåller en avancerad suspension av ofarliga bakteriekulturer samt enzymer som bryter ner illaluktande organiskt material och omvandlar de organiska ämnena till vatten och koldioxid. Källan till dålig lukt avlägsnas således permanent.
Spraya Bio-C på drabbade ytor. Beroende på skadans omfattning, rengör och desinficera eventuellt före behandling med Bio-C. Kontakta NAC för exakta instruktioner om du är osäker.
Avlägsna skadedjuret, om möjligt, spraya med Bio-C och placera Neutrox Gamma Bricks som extra förebyggande av luktproblem. Desinficera området vid behov före behandling med Bio-C.
Sanering av lukt efter lik kan vara mycket komplicerad och omfattande, men Bio-C är en del av NACs metod för att ta bort liklukt. Kontakta NAC för mer information om rekommenderade produkter inklusive Bio-C som kan användas för liksanering. Dekontaminering av lukt efter kroppsfynd beskrivs i NACs nya Odour Management Concept.







Bio-C bryter ner och tar bort dålig lukt från ytor som har varit i kontakt med organiskt avfall, såsom kött, frukt, grönsaker, blommor, bröd, mjölk och ost, etc. Bio-C sprutas direkt på dessa ytor, som vanligtvis finns i avfallsområden etc. Bio-Cs eteriska oljor kommer omedelbart att säkerställa en effektiv luktreduktion och de effektiva mikroorganismerna och enzymerna bryter sedan ner avfallet och omvandlar det till vatten och koldioxid (CO2), detsamma som händer i naturen.
Bio-Cs aktiva bakterier och enzymer säkerställer ett fullständigt avlägsnande av lukt och nedbrytning av fettansamlingar i fettfällor, avlopp och andra installationer som kommer i kontakt med avloppsvatten från livsmedelsindustrin, kommersiella kök, restauranger etc. Doseringssystem kan installeras. Kontakta NAC Europe för mer information.
Bio-C kan injiceras direkt i kåpor/avgassystem i livsmedelsindustrin, kommersiella kök, restauranger etc. med speciella munstycks-/pumpdoseringssystem. Bio-C bryter ner/ avlägsnar fett och håller därmed dessa exponerade platser helt fria från ansamlingar av stekfett, stekolja och andra föroreningar och därmed också fria från luktproblem. Doseringssystemet kan installeras. Kontakta NAC Europe för mer information.
Rengöring/luktsanering av särskilt snuskiga och försummade sociala lägenheter kan utföras med olika Vaportek-produkter. Bio-C kan sprutas direkt på alla porösa såväl som hårda ytor, putsade väggar, tapeter, betong, trä, mattor, gardiner, kakel etc. Rengör först noggrant. I denna process kan du också använda Vaportek ECOZ-vätskor i sköljvattnet eller direkt med doftneutralt rengöringsmedel i själva rengöringsprocessen.
Bio-C bryts ner och tar bort urinlukt från katter, hundar och andra husdjur. Avlägsnar effektivt urinlukt från sänglinne, mattor och alla andra material och ytor på grund av inkontinens hos människor. Avlägsnar urinlukt i och runt urinoaren och är särskilt effektivt för att bryta ner urinlukt från porösa fogar runt urinalen, toaletter etc. Kontakta NAC Europe för specifik information om urinborttagning eftersom det kan vara nödvändigt att kombinera Bio-C med andra luktbaserade produkter som ingår i NACs nya Odour Management Concept.





FÅ
Restorator är en unik, kompakt och mycket mångsidig luktbehandlingsapparat som hjälper dig att omedelbart ta bort lukt och göra dina kunder nöjda. Restoratoren är ett oumbärligt verktyg för tusentals företag inom skadeservice världen över.
Restoratoren är utmärkt att använda omedelbart efter att branden har släckts. Skadelidande, grannar, etc. frustreras av den starka doften av sot. Här kan Restorator tillsammans med andra Vaportek-produkter som Neutrox Gamma Bricks och ECOZ-vätskor hjälpa till att minska den starka och irriterande lukten av rök och sot, vilket resulterar i att klagomål om luktproblem minskas eller helt undviks.




22-23
Restoratoren är särskilt lämplig för permanent avlägsnande av luktproblem efter brand etc. och kan användas under hela saneringsprocessen. Standardproceduren är att tvätta alla ytor med alkaliskt rengöringsmedel och använda ECOZ våt luktsaneringskoncentrat i sköljvattnet och sedan kan du använda en Restorator som tar bort eventuell kvarvarande lukt efter rengöring. Vi rekommenderar att du använder en patron med SOS-olja (Smoke Odour Solution) eller med Neutrox Gamma-olja i Restorator. För att ta bort lätt lukt är våra färska Lemon- och Summer Orange-patroner från vårt Fresh & Clean Citrus Concept mycket populära.

Vatten med alkaliskt rengöringsmedel

Sköljvatten med ECOZ-koncentrat SOS, Classic Neutral, Lemon eller Summer Orange





Använd Vaportek som första hjälpen för lukt. Undvik luktbesvär och få nöjda kunder.




FÅ UT DET MESTA AV
VAPORTEK-PRODUKTERNA OCH FÅ NÖJDA KUNDER
Populär utrustning för att ta bort lukt i bilar, husvagnar, båtar och liknande. Applicera/tvätta vid behov först med Bio-C eller ECOZ vätska på textilier och hårda ytor.
Placera Restorator framför luftintaget på en centrifugalfläkt och sprid effektivt den aktiva torrångan från Restorator till ett större område.



Restoratoren kan användas för luktbehandling av lösöre och textilier. De små vegetabiliska oljemolekylerna från den aktiva torrångan tränger snabbt in i material och textilier. Vi rekommenderar att du använder Vaportek Lemon eller SOS för detta ändamål.
Restoratoren är idealisk för luktbehandling i hotellrum om ett rökförbud inte följs eller för att ta bort alla andra obehagliga lukter i hotellrum som svett, kräkningar, urin, mat etc. Hotellrum som luktar kan inte användas och kostar mycket pengar för varje natt som rummet inte hyrs ut. Om det behövs, spraya först med Bio-C direkt på platser där luktkällan kan upptäckas. Ta först bort luktkällan, t.ex. kräkas på mattor, rengör området och spraya sedan området med Bio-C, använd sedan Restorator som snabbt och effektivt tar bort/eliminerar lukten i hela rummet med den aktiva torrångan. Städerskor på hotell runt om i världen är entusiastiska över Restorator och Bio-Cs förmåga att snabbt, effektivt och miljövänligt neutralisera lukt i hotellrummen.







FÅ UT DET MESTA AV VAPORTEK-PRODUKTERNA OCH FÅ NÖJDA KUNDER
VAPORSHARK
Extremt kraftfull och effektiv enhet för permanent avlägsnande av dålig lukt. Lämnar de behandlade rummen med en ren, fräsch och naturlig lukt. Ett utmärkt och miljövänligt alternativ till ozonbehandling.
Första hjälpen vid extrem röklukt efter brandskador i stora byggnader som varuhus, skolor, köpcentra, fabrikshallar, lager, kontor etc.


Efter en brand i stora områden som beskrivs ovan kan lukten av rök vara en enorm utmaning för anställda och alla andra människor som besöker byggnader med omfattande luktskador. Här tillhandahåller VaporSharken, som en av de få produkterna på marknaden, miljövänlig första hjälpen för att omedelbart minska lukt, förbättra inomhusklimatet och därmed undvika luktklagomål från anställda, gäster, besökare etc.
A: I stora områden kan du placera en eller flera VaporSharks som omedelbart minskar lukten. VaporSharken sprider snabbt den välkända och effektiva luktneutraliserande torrångan från Neutrox Gamma-olja, SOS-olja (Smoke Odour Solution) eller de naturliga citrusoljorna från vårt "Fresh & Clean Citrus Concept", Lemon eller Summer Orange.
B: För mycket stora rum/hallar kan du öka VaporSharks effekt genom att placera VaporSharks luftutlopp framför luftintaget på en centrifugalfläkt (se bild 2), som sedan sprider torrånga över större områden. Du kan använda flera VaporSharks i stora områden och därigenom se till att hela det drabbade området behandlas av Vaporteks luktneutraliserande torrånga till förmån för alla som arbetar eller besöker byggnaden.
C: Alternativt kan du också ansluta en VaporShark till det centrala ventilationssystemet (se bild 1) för att behandla alla rum i byggnaden med aktiv torrånga från bara en VaporShark. Genom att leda en 2" flexslang från VaporSharkens luftutlopp direkt in i ventilationskanalen kommer aktiv torrånga att spridas via ventilationssystemet till alla drabbade rum och därmed eliminera luktproblem.

VaporSharken är utmärkt att använda direkt efter branden. Skadelidande, grannar, etc. är frustrerade över den starka lukten av sot. Här kommer VaporSharken möjligen tillsammans med andra Vaportek-produkter som Neutrox Gamma Bricks och ECOZ vätskor att hjälpa till att dämpa/minska den starka och irriterande lukten av rök och sot och klagomål om luktproblem minskas helt eller elimineras.






VaporSharken är särskilt lämplig för permanent avlägsnande av luktproblem efter en brand och kan användas under hela saneringsprocessen. Standardförfarandet är att tvätta alla ytor med alkaliskt rengöringsmedel och använda ECOZ våtluktsaneringskoncentrat i sköljvattnet och sedan kan du använda en VaporShark som tar bort eventuell kvarvarande lukt efter rengöring. Vi rekommenderar att du använder ett membran med SOS-olja (Smoke Odour Solution) eller med Neutrox Gamma-olja i VaporSharken. För att ta bort lätt lukt är våra färska Lemon og Summer Orange membran från vårt Fresh & Clean Citrus Concept mycket populära.

Vatten med alkaliskt rengöringsmedel

Sköljvatten med ECOZ-koncentrat SOS, Classic Neutral, Lemon eller Summer Orange




Använd Vaportek som första hjälpen för lukt. Undvik luktbesvär och få nöjda kunder.

Placera VaporSharken framför luftintaget på en centrifugalfläkt och sprid effektivt den aktiva torrångan från VaporSharken till ett större område.





VaporSharken kan användas för luktbehandling av lösöre och textilier. De extremt små växtoljemolekylerna från den aktiva torrångan kommer snabbt att tränga igenom material och textilier. Vi rekommenderar att du använder Vaportek Lemon- eller SOS-membran för detta ändamål.


Det kan vara svårt att behandla lukt i svåråtkomliga områden, men här kan VaporShark också hjälpa till. Genom att montera en 2 "flexslang på VaporSharkens luftutlopp kan aktiv luktneutraliserande torrånga riktas in i svåråtkomliga områden, som golvseparationer, kryputrymmen, vindar, under golv och alla andra typer av håligheter där torrånga kan injiceras via flexslangar.












Ledande biltillverkare världen över använder och rekommenderar Vaportek-teknik för sina globala återförsäljarnätverk. Varför?
Därför att Vaportek är miljövänlig teknik som fungerar varje gång och är lätt att använda. Bilar som luktar kan inte säljas – Vaportek löser problemet på ett hållbart och effektivt sätt.
Förutom bilhandlare använder andra branscher och affärsområden också t.ex. Vaporteks Restorator som visas här. Över hela världen tycker hotell, restauranger, fastighetsmäklare, fastighetsföretag, transportföretag, städföretag, skadeserviceföretag, skadedjursföretag, industrin och många andra Vaporteks mångsidiga, miljövänliga och högeffektiva produkter.


Om du är en OEM (Original Equipment Manufacturer) eller på svenska originalprodukttillverkaren och är intresserad av att höra mer hur Vaporteks teknik kan integreras i dina produkter/ produktlösningar, vänligen kontakta oss.
Vaportek arbetar med tillverkare av utrustning och produkter för luftrening, luftraffinering, aromaterapi, produkter för avfallshantering, avloppsvatten etc. Vaportek tillverkar gärna speciallösningar för dina behov och ändamål.
Vaporteks mångsidiga produktsortiment gör att vi definitivt kan hitta en lösning för just dina behov.
Implementera en unik och hållbar lösning i dina maskiner, processer och utrustning etc. för att ta bort eller kontrollera lukt.
Dra nytta av naturens kraft, Vaporteks omfattande erfarenhet och mångsidiga och effektiva produktsortiment. Tillsammans hittar vi den perfekta lösningen.
Vi är intresserade av att höra mer om dina tankar och idéer. Vi erbjuder gärna en kreativ och hållbar lösning. Kontakta oss för ett icke förpliktigande möte!




NAC
NAC Europe grundades 2001 med Vaportek som en av de viktigaste produkterna i vårt då blygsamma produktsortiment.
Sedan 2001 har NAC Europe utökat sitt produktsortiment avsevärt med teknisk utrustning och kemi etc. från ett antal erkända och innovativa internationella tillverkare.
År 2024 presenterade vi vår nya webbplats med ett antal nya produkter, samt flera nya koncept, inklusive ett helt nytt luktsaneringskoncept som bygger på DET BÄSTA AV TVÅ VÄRLDAR
Vaportek är fortfarande och kommer att fortsätta vara ett av våra bästsäljande varumärken, helt enkelt för att tekniken och produkterna från Vaportek är så unika, effektiva och mångsidiga i sin applikation.
Inom branschen är dock NAC Europe känt som företaget som utmanar sina kunder genom att lansera ny teknik som vi tror erbjuder nya och fler fördelar i en bransch som behöver snabba och effektiva resultat.
Vaportek är baserat på naturliga växtextrakt och arbetar genom speciella processer där de naturliga och kraftfulla eteriska oljorna reagerar med luktmolekyler i en process som kallas "Zwaardemaker Pairs". Se sidorna 16-18.
Nu introducerar NAC ett nytt koncept där vi förbinder Vaportek med ny produktteknik som arbetar genom oxidation och adsorption. Med det nya konceptet kommer vi att ge våra kunder möjlighet att kombinera olika luktborttagningsmetoder i syfte att optimera luktreningsprocessen när det gäller hastighet, effektivitet, hållbarhet och användarvänlighet.
Vi hoppas att våra kunder kommer att välkomna detta nya koncept.

Vi har samlat en del av marknadens bästa och senaste teknik inom professionell luktsanering i ett koncept som vi kallar DET BÄSTA AV TVÅ VÄRLDAR . Detta koncept ger dig mångsidighet, kraft, snabba resultat, miljöoch användarvänlighet, hållbarhet och inte minst nöjda kunder.
















BRAND- OCH VATTENSKADESANERING
Skadesaneringsföretag världen över har dragit nytta av Vaportek-tekniken sedan början av 1980-talet och är idag en av Vaporteks kärnkundgrupper. Vaportek-produkter respekteras bland professionella yrkesverksamma inom branschen, eftersom Vaportek ger skadesaneringsföretag många möjligheter att kontrollera och ta bort lukt på ett miljövänligt och användarvänligt sätt. De hållbara Vaportek-produkterna bidrar till ett effektivt och permanent avlägsnande av lukt under hela saneringsprocessen och känne-
tecknas av sin mångsidighet och snabba effekt, särskilt vid plötsliga luktproblem. Vaportek används för brandskador, vattenskador, avloppsskador, luktskador från skadedjur, för dekontaminering av lukt efter kroppsfynd, etc. Vaportek kan användas ensam eller tillsammans med andra luktavhjälpningsmetoder, t.ex. NACs CLO2 (klordioxid) -baserade produkter eller våra H2O2 (väteperoxid) -baserade produkter etc. Kontakta oss för mer information. Vaportek ingår som en nyckelprodukt i NACs nya luktsaneringskoncept "NAC EUROPEs ODOUR MANAGEMENT CONCEPT".
DJURSJUKHUS, KENNLAR OCH HUSDJUR
Lukt från husdjur i privata hem, på sjukhus, kennlar etc. är ett välkänt problem. Vaportek-produkterna används för att neutralisera urinlukt liksom alla andra lukter på både hårda ytor och porösa ytor såsom textilier etc.
Bio-C, Neutrox Gamma Bricks och Restorator-maskinen är exempel på Vaportek-produkter som hjälper till att avlägsna och minska irriterande lukt efter alla typer av husdjur.
RENGÖRINGSINDUSTRIN
Behovet av att ta bort och kontrollera dålig lukt är emellertid alltid relevant i många inomhusmiljöer och här kan de mångsidiga Vaportek-produkterna som är baserade på 100 % naturliga ingredienser vara till stor hjälp. Lukten kan komma från flera källor som. urin, hushållsavfall, tobakslukt, kräkningar, avlopp, mögel, svett, etc. och med det breda Vaportek-sortimentet hittar vi alltid en lösning tillsammans med våra kunder för att effektivt och hållbart kontrollera och ta bort dålig lukt. Rengöring
Rengöringsindustrin kan effektivt utnyttja Vaportek-tekniken. De senaste åren har trenden inom städindustrin varit att rengöra med produkter som är Svanenmärkta och inte innehåller dofter. Konstgjorda dofter maskerar bara den dåliga lukten och är därför inte en hållbar lösning på luktproblem i institutioner som skolor, vårdhem, sjukhus, industriföretag etc.



FASTIGHETSTJÄNSTER OCH
FASTIGHETSMÄKLARE
Lukt i lägenheter och hus som härrör från många års rökning, husdjur, urin, dödsfall, mögel etc. kan vara en stor utmaning att ta bort när nya hyresgäster och köpare måste ta över hemmet.
Med nästan 20 års erfarenhet inom skadeservicebranschen har NAC Europe kompetens och produkter för att effektivt förvandla en illaluktande egendom till en 100 % luktfri! Resultat inga klagomål vid förvärv samt snabbare försäljning av fastigheter.
HÄLSOSEKTORN
Sjukhus, vårdhem, bostadsrättsföreningar, grundskolor plågas ofta av lukt från urin (inkontinens), avföring, kräkningar, svettningar, tobakslukt etc. I slutet av sjuttiotalet utvecklades Vaportek-tekniken ursprungligen för att avlägsna dålig lukt
VÄXTHUS/CANNABIS-PRODUKTION
Användningen av olika typer av gödselmedel och andra näringslösningar, hög luftfuktighet och bakterietillväxt etc. kan leda till luktproblem i växthus i allmänhet. Med den ökande ökningen av cannabisproduktion för medicinska ändamål har luktproblem även uppstått i samband med detta. Cannabisväxten producerar terpener som är ansvariga för den karakteristiska lukt som växten avger. Terpener är starkt luktande kolväten som bildas i växten i syfte att skydda sig från växtätare eller genom att locka "rovdjur" som
på canceravdelningar på amerikanska sjukhus och framgången här skapade grunden för Vaporteks globala framgång. Idag används Vaportek-produkter i tusentals institutioner runt om i världen, där lukt kontrolleras på ett effektivt och hållbart sätt.
äter växtätare. Lukten av cannabis kan bli ett stort problem för grannar till cannabisproducerande anläggningar. Vaporteks aktiva torrånga bestående av många olika växtextrakt (eteriska oljor) har under ett antal år visat sig vara mycket effektiv när det gäller att eliminera lukten från de starka terpenerna. Kontakta NAC Europe för mer information. NAC Europe erbjuder både Vaportek luktbehandlingsprodukter samt avancerade desinfektionsmedel för desinfektion av bevattningsvatten inom professionell växtproduktion. Fastighetstjänster







HOTELL- OCH RESTAURANGBRANSCHEN
Inga hotellgäster accepterar dålig lukt i hotellrummen. Lukt i hotellrum som härstammar från lukten av tobak, kräkningar, svett, mat etc. gör rummet omöjligt att hyra och kostar hotell mycket pengar i förlorade intäkter och anseende varje år. Ledande hotellkedjor runt om i världen använder Bio-C flytande koncentrat. Neutrox Gamma Bricks, Aroma Bricks
eller Restorator-maskinen etc. för supereffektivt och fullständigt avlägsnande av lukt på 30-60 min. eller kortare, med garanti. Oavsett om det handlar om lukten av matos, avfallslukt, röklukt, kräkningar, urinlukt - i hotellrum, hotellkorridorer, toaletter, avfallsrum etc. Det finns alltid en eller flera Vaportek-produkter som löser uppgiften omedelbart.
Livsmedelsindustrin, reningsverk, avfallsförbränning, biogasanläggningar, benmjölfabriker etc. har gemensamt att alla har en eller flera produktionsprocesser som på ett eller annat sätt orsakar dålig lukt hos företaget.
Det kan vara lukt i produktionshallar, lukt från avloppsvatten, lukt från fettfällor, lukt från lagring av råvaror, lukt i avfalls-
rum etc. som sprider sig till angränsande utrymmen och anläggningar till stora besvär för anställda, besökare etc.
Vaportek-produkter som Bio-C, VaporShark, Neutrox Gamma Bricks, HeavyDuty Stand Alone patroner etc. används över hela världen för effektiv behandling och neutralisering av lukt i många olika branscher.
Transportbranschen kan ha många utmaningar med lukt i bilar, lastbilar, containrar etc.
En lastbil eller behållare som har haft ett luktproblem, till exempel på grund av transport av illaluktande varor, kan inte användas igen förrän lukten är borta, eftersom starka lukter vanligtvis avger
lukten till nya varor och tränger igenom kartonger och andra material. Dessutom är luktproblem också ett problem i många personbilar på grund av cigarettrök, hundtransport, svettlukt och många andra orsaker. Vaportek har många olika lösningar som kan eliminera lukt i transportbranschen.
Vaportek FAKTUM
Luktsansen är kopplat direkt till det hjärnområde som kallas det limbiska systemet som styr minne, känslor och instinktivt beteende. Luktar det rent och gott när du har slutfört ditt skadaservicejobb - upplevs det av kunden som positivt. Det ger positiv branding för ditt företag och stärker därför din konkurrenskraft avsevärt.

Vaportek FAKTUM
Vaportek-metoden är inte en maskering af lukt, men en luktneutralisering baserad på användning av "VAN DER WAALS FORCES" och "ZWAARDEMAKER PAIRS". Se sidorna 16-18.


Vaportek-produkter är REN VÄXTENERGI
BASERAD PÅ DE BOTANISKA NATURKRAFTERNA
Vaportek-produkter är
Vaportek-produkter är EKONOMISK I BRUK
Vaportek-produkter ger dig många MÖJLIGHETER

TA 100 % KONTROLL ÖVER DINA

LUKTSANERINGSUPPGIFTER



